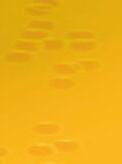

De stap zetten om te doen wat je eigenlijk niet durft

ZONDAG 28 MEI
Zie pagina 17 t/m 25



Pieter Pooyé

dere situaties in je leven doen. Je herkent het dan. Oh, dit is stress, hoe kan ik daar mee om gaan? Door bijvoorbeeld rustig te ademen en te weten dat je baas bent over je lichaam. “
Applaus
elkaar aan en geven elkaar kracht.
Jesse, student opleiding Social Work van Avans en stagiair op de Shelter, heeft vroeger met een vriend regelmatig in koud water gezwommen en maakte kennis met de Wim Hof koude training. “Hier krijg je echt een kick van. Je lichaam krijgt een sterke stress prikkel door de kou en daarna voel je je heel erg levendig. Het geeft ook ontspanning. Dat leek me een leuk idee voor de gasten van de Shelter”, vertelt hij. Sinds een half jaar begeleidt hij dat elke zaterdag om 3 uur. Eerst begint men met sport en flinke ademhalingsoefeningen om op te warmen. En dan stap je, onder begeleiding van Jesse, die de tijd stipt bijhoudt, een paar minuten in het bad dat is gevuld met water en ijs. “Gewoon gaan zitten en goed uitademen”, legt hij uit.

Overwinning “Tegenwoordig zijn we veel te verwend met kleding en verwarming. Ons immuunsysteem is daardoor verzwakt. Door dit ijsbad prikkel je dat. Je leert ook de stressimpuls beheersen. Je lichaam schreeuwt dat je eruit wilt en komt in de stress. Je moet vol blijven houden om rustig te blijven ademen. Als je die stress van de kou de baas bent, dan kan je het op andere momenten ook leren toepassen. Het past daarmee heel goed binnen de doelstelling van de Shelter”, vertelt Jesse; “Je zet de stap om dit te doen, je durft het, en overwint jezelf hiermee.” David vult aan “Je lichaam weet; het gaat niet echt fijn worden en dan push ik mezelf. Ik neem het besluit om het toch te doen. Je hoofd zegt ‘ik ben de leider’. Als je dat een paar keer traint dan leer je dat ook op an-

Inmiddels hebben al 20 tot 30 mannen, vrouwen en kinderen deze activiteit een keer meegedaan. Vandaag doet de dappere kleine Liam voor het eerst mee en het gaat heel goed, hij wil er nog eens in. Voor sommigen is het met één keer genoeg en anderen komen wekelijks terug. “Het is ook een leuk sociaal gebeuren. De waarde zit erin dat we dit met een groep doen en we moedigen
Het is meer mentaal dan een fysiek iets”, vertelt David. “Iedereen ondersteunt elkaar en krijgt een applaus als je het hebt gedurfd. Het wordt gedragen door alle gasten. Iedereen is welkom. Dus kom eens langs als je mee wilt doen. Je kunt ook de sport of ademhalingsoefeningen doen en niet in het bad gaan.” Nic, een van de gasten van de Shelter gaat het straks van Jesse overnemen, en demonstreert enthousiast de Fire Breathing ademhalingsoefening. Nic vertelt dat hij door bijna elke week een ijsbad te nemen, nu beter met stress van zijn verslaving omgaat. “Het is belangrijk voor mij om stress op
te zoeken op het moment dat het mij goed uitkomt. Sport en ijsbaden helpen mij om mentale weerstanden opzij te zetten. Ik kan mezelf dan uitdagen en grenzen verleggen. Ik heb er ’s morgens ook geen zin in. Maar dan gaan doen wat goed voor mij is, door tegen de weerstand te gaan, tegen de bla bla in mijn hoofd, dat levert mij veel op. De verbinding met mensen is ook zo belangrijk. We geven elkaar kracht”, zegt Nic. “Je kunt met elkaar open over je ervaringen praten.” Uw correspondent wordt door Nic ook uitgenodigd om een ijsbad te nemen. Ze heeft de uitdaging aangenomen en echt, het was heerlijk!



adres voor al uw familiewerk








geboortekaartjes • trouwkaarten • jubileumkaarten

Een bijzonder moment vraagt natuurlijk om een heel persoonlijke keus. Daarvoor bieden wij u een uitgebreide collectie kaarten van alle toonaangevende uitgevers.

Vanzelfsprekend is er ook de mogelijkheid voor een eigen uniek ontwerp. Bij geboorte, verloving, huwelijk, jubileum of voor een andere bijzondere gelegenheid. Neem tijdig contact met ons op voor een creatieve vertaling van uw blijde boodschap.
tot 19.30 uur www.leijtenbv.nl



Koninklijke drukkerij Em. de Jong zoekt jou!
Koninklijke

Machine Operator
Machine Operator
Ben jij op zoek naar:
Ben jij op zoek naar:
•Een uitstekend salaris?
Ben jij dé fanatieke, gedreven chauffeur die ons team komt versterken? Als chauffeur bezorg je het door ons gemaakte drukwerk op diverse adressen, zowel bij klanten als verspreiders, veelal binnen de Benelux. Jij bent dus letterlijk het visitekaartje van ons bedrijf!
•Een uitstekend salaris?
• Met ploegendiensten nog meer verdienen?
• Met ploegendiensten nog meer verdienen?
Ben jij op zoek naar:
• Een afwisselende baan als chauffeur

• Zonder ervaring werken met de nieuwste technologie bij de grootste drukker van Europa?
• Zonder ervaring werken met de nieuwste technologie bij de grootste drukker van Europa?
• Vrijheid en zelfstandigheid in je werk
• Uitgebreide ontwikkelingsmogelijkheden?
• Uitgebreide ontwikkelingsmogelijkheden?
• Een team met enthousiaste collega’s en een informele werksfeer

• Werken in een geweldig team bij een gezellig familiebedrijf?
• Werken in een geweldig team bij een gezellig familiebedrijf?
Bekijk al onze vacatures op werk.emdejong.nl
Bekijk al onze vacatures op werk.emdejong.nl

Afgelopen januari is er op de verpleegafdeling van Maria-Oord een wensboom gekomen. Bewoners kunnen hier hun wens in ophangen die gedurende het jaar dan met behulp van familie en personeel uitkomt. Donderdag 11 mei gingen we op pad met Jan Vrinten. Jan is een natuurman pur sang. Hij weet alles over bloemen, planten, bomen en vogels. We werden hartelijk ontvangen bij Peter en Elly Verschure aan de Groenstraat. Peter wist niet wie er zou komen en toen Jan uitstapte en hij hem herkende was er meteen een feestelijke sfeer. Jan en Peter hebben namelijk samen natuurwandelingen georganiseerd. Het weer was ons goed gezind en de zon deed goed zijn best.
Peter leidde ons rond in de prachtige tuin en vertelde allerlei informatieve en leuke verhalen. Jan
Genieten in de tuin
Filmprogramma komende weken
Zomer in Frankrijk –donderdag 25 mei
genoot volop en noemde regelmatig de vogelsoort als hij een vogel hoorde fluiten. Hij stelde vragen aan Peter als hij twijfelde over een bloem- of plantsoort maar eigenlijk had hij het zelf altijd al goed. Nadat we bijna anderhalf uur in de tuin hadden doorgebracht had Elly nog een lekker kopje koffie voor ons gezet. Samen met de door ons meegebrachte worstenbroodjes zaten we heerlijk onder de overkapping en zat Jan nog na te genieten met uitzicht op de tuin. Het was een zeer geslaagde middag waar Jan nog steeds met plezier op terugkijkt. Peter en Elly, nogmaals onze dank voor jullie gastvrijheid. Hierdoor hebben wij weer een wens in vervulling kunnen laten gaan.

Jan - Wim - Debbie
14e editie zomeractiviteiten voor senioren
Sinds de start van de zomeractiviteiten voor senioren in de gemeente Dongen in 2008 hebben al vele senioren iedere zomer deelgenomen aan de diverse activiteiten in Dongen en omgeving.
Ook dit jaar is de werkgroep van SWOD actief bezig geweest. Ze hebben leuke activiteiten uitgezocht en voorbereid. Zorg er daarom voor dat u een boekje te pakken krijgt en ga mee op pad. Er is volop te kiezen, want de werkgroep heeft maar liefst 24 activiteiten voor u georganiseerd. Er is een grote diversiteit aan gezellige culturele, sportieve, culinaire en educatieve ac -
tiviteiten uitgezocht voor deze zomermaanden. We vragen u om zich zoveel mogelijk via de website www. swodongen.nl aan te melden. Natuurlijk zijn er ook weer boekjes beschikbaar. Deze zijn te verkrijgen op de volgende locaties: MIjzo, Stichting Welzijn Ouderen Dongen (SWOD), de Leest, Ontmoetingsruimte Europlus, Ontmoetingsruimte Dr. Maassen,
Politiek
Jeu de Boules, de Cammeleur, de Geubel en Coop ‘s Gravenmoer. De activiteiten worden deze zomer georganiseerd tussen 17 juli en 12 augustus. De uiterste inschrijfdatum is 23 juni.
Heeft u vragen? Het kantoor van SWOD, Dongepark 1, is alle werkdagen geopend van 09.00 uur tot 11.30 uur. Per e-mail zijn we te bereiken op activiteiten@ swodongen.nl en telefonisch staan we tijdens onze openingsuren graag voor u klaar op 0162375296.

Pinksterviering met Gospelkoor in Oude Kerk Dongen

Tijdens een zinderende zomer in Frankrijk worden de verhoudingen tussen twee gezinnen behoorlijk op zijn kop gezet. Na een jarenlange vriendschap ontstaan er tijdens de gezamenlijke vakantie ineens gevoelens tussen vader Walt en Marie, de moeder van het andere gezin. Om de situatie zo goed mogelijk op te lossen proberen ze ook een nieuwe liefde aan te wakkeren tussen hun wederzijdse partners. [De toegangsprijs voor deze film is voor alle bezoekers € 8,-; ledenkaart is niet geldig]
Revoir Paris –woensdag 31 mei

Drie maanden na het overleven van een terroristische aanslag op een Parijse bistro herinnert Mia zich slechts flarden van de gebeurtenissen. Ze besluit haar stappen van die noodlottige avond na te lopen in de hoop dat wanneer ze zich meer herinnert, ze haar leven weer op kan pakken.

Zomerstop
Hiermee is een einde gekomen aan het filmseizoen 2022-2023.
Op woensdag 30 augustus pakken we de draad weer op met de eerste film van het nieuwe filmseizoen. Het bestuur en de vrijwilligers van Cinema Dongen wenst iedereen een prettige zomerperiode.

Te trage en te dure laadpalen
In Dongen rijden er ongeveer 423 elektrische auto’s lazen we in BN DeStem van 11 mei 2023. Sinds 2021 is het aantal volledig elektrische voertuigen bijna verdubbeld. De verwachting is dat dit aantal verder stijgt naar 2000 auto’s in 2030. Een goede ontwikkeling. We willen deze auto’s uiteraard allemaal kunnen opladen en dat betekent dat er steeds meer laadpalen in de gemeente Dongen nodig zijn.
Vragen over laadpalen
Over die laadpalen kreeg D66 Dongen een aantal maanden geleden een vraag. Een inwoner uit de Beljaart gaf aan dat er in hun wijk een aantal laadpalen staan waar het opladen heel traag gaat. Met als gevolg dat de laadpalen die snel opladen continu bezet zijn en dat de trage laadpalen veel minder worden gebruikt. Wij vroegen de wethouder hoe dit nu precies zat en kregen als reactie dat er in de Beljaart inderdaad verschillende type laadpalen staan en dat de keuze hiervoor bewust is gemaakt. Niet alle (met name oudere modellen) auto’s kunnen namelijk bij een snelle laadpaal opladen. Verder gaf de eigenaar van de laadpalen aan dat er geen problemen zijn en hiermee was onze vraag afgehandeld.
Hoelang duurt opladen in Dongen en wat kost dit?
een batterij van 70kW duurt dan 6,5 uur. De nieuwe palen zijn van LMS (Beljaart - West 1 &2). 25% van deze palen is 17 KW, laden duurt dan 4 uur. 75% is 5,8kW, dan duurt het laden maar liefst 12 uur en dat is veel te lang. De prijs per kWh ligt tussen de € 0,53 (LMS) en € 0,65 (Allego).
Collectieve inkoop laadpalen door de provincie

De gemeente Dongen deed niet mee met de collectieve inkoop van laadpalen door de provincie.
Oosterhout en Goirle wel. Daar plaatst Vattenfall laadpalen, van minimaal 11kW (5,5 uur laden) en voor € 0,40 per kWh. In deze gemeenten kan dus bij veel palen sneller geladen worden en is een laadsessie bij een lege accu tot wel €10 goedkoper.
Laadstress
Als in 2030 de helft van alle elektrische auto’s in Dongen bij een openbare laadpaal moet laden dan voorziet D66 Dongen niet alleen veel laadfiles met bijkomende stress, maar zijn inwoners met een elektrische auto ook een half miljoen euro per jaar duurder uit dan in de gemeenten die wel meededen met de collectieve inkoop.
Absoluut geen wenselijke situatie. D66 Dongen zet zich deze bestuursperiode daarom in voor een goede en toekomstbestendige laadinfrastructuur in Dongen. Onder andere door aanvullende raadsvragen over dit onderwerp te stellen. Daarnaast horen we graag over uw ervaringen met laadpalen in Dongen. Dit kan via mail (m.schouten@d66dongen. nl) of via de Facebookpagina (facebook.com/d66dongen) of persoonlijk als u ons tegenkomt op straat. Alvast hartelijk bedankt voor uw reactie!
De fractie van D66 Dongen, Joeri de Jong, Ulaș Kose, Gitta Glerum - Camfferman en Marieke Schouten
Gospelkoor TICGC.
De Pinksterviering van de Protestantse gemeente van Dongen en Rijen zal op 28 mei worden opgeluisterd door het enthousiaste Gospelkoor TICGC uit Tilburg.
Deze naam staat voor “The International Community Gospel Choir”. Het is de eerste keer, dat zij in deze kerk te gast zijn. Het
koor staat onder leiding van Wibo Hijink en wordt op de piano begeleid door Erik van der Kroft. Ook beschikt het over een uitstekende soliste. Op hun repertoire treffen we black gospel songs aan. Het koor is bekend door deelnames aan diverse concerten, optredens, televisieopnamen en tours
van diverse artiesten. De deur van de Oude Kerk aan de Kerkstraat 56 gaat op Pinksterzondag 28 mei om half 10 open. De viering zelf begint om 10 uur. Voorganger is ds. Henrieke ten Thije. Laat je verrassen en kom meegenieten en meezingen.
Na dit antwoord zijn wij zelf eens wat beter in het onderwerp gedoken. Welke typen laadpalen staan er in Dongen en hoelang duurt het opladen bij deze palen? En wat kost opladen aan een laadpaal eigenlijk?
Een elektrische auto gebruikt gemiddeld 18 kWh per 100 km. Voor een actieradius van 400 km is een batterij van minimaal 70kW nodig. In Dongen staan openbare laadpalen van de exploitanten Allego en LMS. De laadpalen van Allego zijn 11KW. Het laden van
5,
7,50

10,15,- 20,- 25,- 30, -


Expositie Fotoclub Pix4Profs van 27 mei t/m
4


juni in de Steenfabriek Gilze
Pubquiz ‘s Gravenmoer
Op vrijdag 2 juni vindt van 19.30 tot 23.00 uur in Dorpshuis de De Geubel in ’s Gravenmoer weer de pubquiz plaats. David Jansen en Martijn de Laat presenteren deze gezellige quiz. Zij worden daarbij geassisteerd door quizlegende Meneer Sjon, het enige jurylid Leo. In 8 gevarieerde rondes nemen teams het tegen elkaar op. De onderwerpen zijn zeer divers en er is altijd voor elk wat wils in te vinden. Ook zijn de muziekronde en plaatjesronde een vast onderdeel. Deze zorgen meestal
voor heel wat hoofdbrekens bij de quizdeelnemers. Uiteraard is plezier en gezelligheid het belangrijkste van de avond. Wie gaat er dit keer aan de haal met de hapjesschaal? Buren, familie, vrienden: vorm een team en meld je aan! Dat kan door een mail te sturen naar davidjanss@ gmail.com of martijndelaat79@ hotmail.com. Van de deelnemers zal een kleine bijdrage worden gevraagd voor het dekken van de kosten. De pubquiz ’s Gravenmoer is een initiatief van Stichting De Geubel.
Gebeurtenissen van de afgelopen 2 weken
We naderen de maand juni, de zomer komt eraan. Afgelopen week liepen de temperaturen al op en ook de komende week blijft het aangenaam. Geniet van het mooie weer.
Getuigen gezocht!
foto: Peter Buitenhuis met de titel: Stoffen in kleur.
Graag willen we een aantal gegevens van een artikel van vorige editie rectificeren. De data dat de expositie geopend is was niet juist weergegeven in de koptekst. Voor de volledigheid bij deze de openingstijden, toegang is gratis:

zaterdag 27 mei en zaterdag 3 juni: 13.00-20.00
zondag 28 mei en zondag 4 juni: 13.00-18.00
• maandag 29 mei: 13.00-20.00 woensdag 31 mei: 14.00-20.00 De bijgevoegde foto was van Peter Buitenhuis met de titel: Stoffen in kleur.
Rectificatie artikel tentoonstelling Fotoclub Pix4profs in Gilze
In het artikel over de tentoonstelling van Fotoclub Pix4profs in Gilze zijn helaas een paar foutjes geslopen. De openingstijden stonden verkeerd vermeld in de inleiding. De juiste openingstijden zijn zaterdag 27 mei en 3 juni van 13.00-20.00 uur, zondag 28 mei en 4 juni van 13.00-18.00 uur, maandag 29 mei van 13.00-20.00 uur en woensdag 31 mei van 14.00-20.00 uur. De

tentoonstelling is in de Steenfabriek, Steenfabriek 7, 5126 PB, Gilze. De toegang is gratis. De naam van de fotograaf en de titel van de foto waren niet juist. De geplaatste foto heet: ’Stoffen in kleur’, en is van Peter Buitenhuis. Excuses voor de gemaakte fouten.
Avondvierdaagse
’s Gravenmoer 2023


Van dinsdag 6 t/m vrijdag 9 juni organiseert O.N.I. gym de 46e avondvierdaagse van ’s Gravenmoer! Start- en finishpunt dit jaar is basisschool De Wegwijzer, Grutterijstraat 27 te ‘s Gravenmoer. Afstanden 3,5 - 5 - 10 km. Start vanaf 18.00 uur.
Voor inschrijving individuele vrij lopers en groepen kan op woens-
Pinksteren
Op dinsdag 2 mei 2023 om 19.45 uur zijn er op de parkeerplaats aan de Mgr. Schaepmanlaan, ter hoogte van de Mgr. Ariensstraat in Dongen, een 19-jarige jongen en zijn vriendin mishandeld. Zij stonden daar geparkeerd met een zwarte Volkswagen Golf en verkochten Vapes. Ze zijn toen mishandeld en door een groep van ongeveer 7 jongens beroofd van hun handel en geld. De politie is op zoek naar getuigen. Hebt u iets gezien en of gehoord, neem dan contact op met 0900-8844 of via Meld Misdaad Anoniem 0800-7000 onder vermelding van proces-nummer: 2023109021.


Save the date 3 juni 2023
Op zaterdag 3 juni, organiseert de gemeente Dongen in samenwerking met de politie een veiligheidsmarkt. Er zullen onder andere de politie, brandweer, gemeente en boa’s aanwezig zijn. Er zullen demo’s gegeven worden en voor de kleinste hebben we zelfs een springkussen. U bent van harte welkom, van 10.00 uur tot 16.00 uur op het Wilhelminaplein in Dongen. Voor een gezellig praatje of om gewoon te kijken.

medewerker van de bank. Uw pincode kunt u meteen wijzigen door na een piepje uw huidige code in te toetsen en na een volgend piepje een nieuwe. Zodra dit gedaan is, vraagt de bankmedewerker uw bankpaslezer, de Rabo Scanner, in een envelop te doen en uw huidige bankpas te verknippen. U moet daarbij de chip niet doorknippen. Dan geeft de bankmedewerker, die uiterst betrouwbaar overkomt, u een unieke code. Degene die uw pas komt afhalen, weet deze code ook en zal deze noemen, zodra hij uw verknipte pas en Scanner komt ophalen.
Tringgg.. de bel gaat. Er staat een net geklede jongeman voor de deur die zich bekend maakt als medewerker van de Rabobank. Hij noemt de unieke code die u net aan de telefoon gehoord had en u geeft hem de scanner, uw verknipte bankpas én een briefje met uw oude pincode, want dat moest ook nog.
dag 31 mei a.s. bij de gymzaal op sportpark Het Wiel te ’s Gravenmoer tussen 19.00 en 20.00 uur. Kosten voor inschrijving € 4,-. Na inschrijving individuele vrij lopers is nog mogelijk op dinsdag 6 juni a.s. van 17.30 tot 17.45 uur bij basisschool ‘De Wegwijzer’. Kosten na inschrijving € 5,-. De wandelsportbond stelt als eis, dat voor elke individuele loper een inschrijfkaart aanwezig is (verzekering-technisch). Indien u inschrijft voor meerdere personen, dient u van deze personen de volgende gegevens bij de hand hebt: naam, adresgegevens, geboortedatum, telefoonnummer. Voor meer informatie kunt u contact opnemen met Heidi van Dalen: secretariaat@ONI-gym.nl


Een gewaarschuwd mens telt voor twee
We zien het in den lande nog veel gebeuren. Dus hier opnieuw de waarschuwing!
Stel, u wordt gebeld door een medewerker van de Rabobank, ING Bank of een andere bank, die u vertelt dat er een grote transactie van uw rekening gaat plaatsvinden. Hij legt u uit dat het waarschijnlijk een criminele bende is die dit gaat doen. U kunt dit voorkomen door een andere pincode te nemen en uw pas af te geven aan een andere
Dit verhaal mag natuurlijk niet waar zijn, maar helaas is het de bittere werkelijkheid. Het is al heel veel mensen overkomen en binnen een uurtje zijn de bankrekening én alle spaarrekeningen leeggehaald.
Wat wel waar is dat de Rabobank of wat voor bank dan ook NOOIT om uw pincode, bankpas of andere gegevens vraagt. Niet in een mail, niet in een brief, niet in een sms en al zeker niet telefonisch! Wordt u gebeld door ‘uw’ bank, hoe betrouwbaar het ook lijkt of klinkt: doe niets en hang op. Vertel het door aan ouders, buren, ooms en tantes. Veel slachtoffers van deze trucs zijn boven de 60 jaar oud.
Zie hiervoor andere bronnen: https://www.politie.nl/onderwerpen/bankhelpdeskfraude.html https://www.maakhetzeniettemakkelijk.nl/senioren-en-veiligheid Wij wensen u een veilige week toe.
Geef voor een toekomst waarin we nierziekten kunnen genezen. nierstichting.nl
Rouwberichten
Met al haar levenslust en wilskracht heeft zij deze strijd niet kunnen winnen.Wij zijn bedroefd, maar ook dankbaar dat haar verdere pijn bespaard is gebleven.
Na alle fijne jaren die wij met haar mochten beleven, hebben wij met veel verdrietafscheid moeten nemen van mijn lieve vrouw, onze moeder en oma
Anneke de Bruin-van Baal

5 Breda, 15 november 1950
4Dongen, 19 mei 2023
echtgenote van Hans de Bruin
Hans Arno en Linda Romy,Jaydi Marcel en Marieke Daantje,Liv

U kunt afscheid nemen van Anneke op vrijdag 26 mei van 18.30 tot 19.15 uur in het uitvaartcentrum van coöperatie DELA, Groenstraat 14a in Dongen.
De afscheidsdienst wordt gehouden op zaterdag 27 mei om 12.00 uur in de aula van crematorium Huis van Brabant, Florijnstraat 60 in Oosterhout.

Corr.adres: Coöperatie DELA o.v.v. Mw. de Bruin-van Baal Groenstraat 14a, 5101 PB Dongen

En God zal alle tranen van hun ogen wissen, en de dood zal er niet meer zijn; ook geen rouw, jammerklacht of moeite zal er meer zijn.
Openbaring 21:4
Na alle fijne jaren die wij samen met haar mochten beleven, hebben wij afscheid moeten nemen van mijn lieve vrouw, onze zorgzame moeder en trotse oma
Mieke Mantelvan de Lagemaat


✩ Ottersum, † Dongen, 17 november 1953 13 mei 2023
echtgenote van Arie Mantel
Jaap en Lesley Mantel
Arya, Willow, Alexis, Hazel Red Deer, Canada
Maaike en Michael Beech Great Stambridge, Engeland
Jirsca en Sjoerd Simons
Tijn
Breda, Nederland
De Ruyterstraat 5, 5102 BP Dongen
De begrafenis heeft op maandag 22 mei plaatsgevonden.
De helpende hand als een dierbare wegvalt 0162 - 31 24 35 of 06 - 29 46 32 50 Postbus 80 - 5100 AB Dongen www.uitvaartverzorgingvanberkel.nl
Na alle fijne jaren die we samen met hem mochten beleven, hebben we toch nog onverwacht afscheid moeten nemen van mijn lieve man, ons pa en opa
Albert Damen
5 Tilburg, 12 januari 1942 4 Dongen, 20 mei 2023 echtgenoot van Corrie Damen-Siemons
Corrie Antoinette en Peter Sylvana en Mike Michael
De crematie zal in besloten kring plaatsvinden.
Corr.adres: Coöperatie DELA o.v.v. Dhr. Damen Karel Boddenweg 3, 5044 EL Tilburg
een afscheid precies zoals u wilt
U bent altijd welkom voor een open gesprek.
Bel 0162 - 47 13 57 of ga naar monutawestenenholterman.nl
Westen en Holterman
Afscheidbegintnemen
Els Heijkant
bij vasthouden wat je lief is.
v.l.n.r. Maarten van Bavel, Lianne van Oosterhout, Nathalie van Schie, Marie-José Schapendonk, Erna Jansen, Antoine Bruijns Florijnstraat 60 | 4903 RM Oosterhout T 0162 457 775 | www.bruijns-uitvaart.nl
NELLY VERKOOIJEN - SCHEERDERS
Na een avontuurlijk begin, 60 jaar lang en gelukkig getrouwd

Wethouder Kees de Jong feliciteert het echtpaar. Foto Casper van Aggelen / Pix4Profs
Jan en Nelly komen beiden uit erg grote gezinnen. Jan was achtste van de elf in een gezin met zes jongens en vijf meisjes. Het gezin van Nelly was nog groter; twaalf kinderen waarvan zij nummer zes was. “Het heeft z’n voor en z’n tegen, zo’n groot gezin”, vertelt ze. “Er werd nogal eens ‘nee’ gezegd, maar het was tegelijkertijd heel gezellig. Er was altijd wel iemand thuis.”
Door Ruth Wilmans

Ze schelen drie en een half jaar, Jan is van 1937 en Nelly van 1940 en ze ontmoetten elkaar bij een toneeluitvoering van de KPJ in Dongen-Vaart. “Het was helemaal vol die avond”, vertelt Jan. “Er was geen stoel meer over. Maar ze mocht wel op mijn knie zitten”, vertelt hij lachend. Ze vonden het beiden blijkbaar heel gezellig en na zijn diensttijd trouwden ze. Jan kwam uit Dongen en Nelly uit Dongen-Vaart. In beide gezinnen was het moeilijk de eindjes aan elkaar te knopen en leerde je al vroeg hard mee te werken. Jan werkte mee op de boerderij en na de vakschool voor de fruitteelt werkte hij overal waar ze hem konden gebruiken. Nelly werkte na de huishoudschool bij diverse gezinnen.

Avontuur
Na hun trouwen namen ze een grote en avontuurlijke stap. Ze gingen wonen op het eiland ‘De Nieuwe Polder’ in de Biesbosch. Jan werd daar bedrijfsleider op een groot fruitbedrijf en het was
daar gratis wonen! Als pasgetrouwd stel was dat vast heel romantisch. Het eiland was per boot een uur varen naar Woudrichem. Ze woonden samen in een groot huis en voor de enige buren, moest je 20 minuten rijden met de trekker. Nelly had wel eens heimwee want ze kwam uit dat grote gezin. Dan zag ze uit het zolderraam een kerktoren en stelde zich voor dat het de kerk van Dongen-Vaart was. Ze moest dan wel eens naar huis, met de boot en dan de brommer. Even thuis zijn en dan was het goed. Ze ging dezelfde avond weer terug.
Bevalling
Na het leven in een groot gezin ben je dan ineens met z’n tweeën. “Je bent wel van elkaar afhankelijk, maar het ging eigenlijk vanzelf” zeggen ze. “Je moet de knop omzetten, want dit was ons toekomst.” Ze legden met die houding de basis voor hun lang en gelukkig huwelijk. Maar het was niet altijd gemakkelijk. ’s Nelly moest bijvoorbeeld haar boodschappen met de boot doen. Winters was dat best moeilijk als het water dichtvroor. In 1965, het derde jaar in de Biesbosch, was Nelly hoogzwanger. Er was geen vroed-
vrouw. Nelly was alleen. Jan was er op uit gegaan met de boot om de dokter op te halen. Toen die op het eiland aankwam, was zoon Jan al geboren. Dat had de dappere Nelly helemaal alleen gedaan. Wat een moedige vrouw! Een van de zusters van Woudrichem bleef daarna een paar dagen als kraamverpleegster. Later kwam die zuster nog eens, samen met wat andere zusters, zwemmen bij hun op het eiland. Want dat zag toch niemand.
Wilt u van uw emotionele of angst problemen af?
Hypnose kan eenoplossing zijn!
voor info: Marjolein Gerritsen


Telnr: 065478942
www.hynocura.nl
Feest
In het vijfde jaar werd het bedrijf in de Biesbosch verkocht en verhuisden ze naar Oosterhout, waar in 1968 dochter Monique werd geboren. Ze verhuisden daarna naar Dongen om een aardappelschilbedrijf te starten aan de Procureurweg. Het bedrijf raakte echter ingebouwd en ze moesten op zoek naar een nieuwe bedrijfsruimte. Die vonden ze aan de Klein Dongenseweg.
Jan en Nelly bij hun trouwen.
OP STAP DOOR EEN VAN DE OUDSTE STRATEN IN DONGEN
Wandeling door de Kerkstraat
Op zondag 28 mei kunt u aan de wandel in de Kerkstraat. In deze straat ontdek je een verrassend stukje Dongen. Het is een van de oudste en mooiste straten en kent een boeiende geschiedenis.
Bezoek toren
Tijdens de wandeling wijzen oude keien de weg naar de ‘Oude Kerk’. Een bezoek aan de toren mag dan ook niet uitblijven. Deze heeft onder andere dienstgedaan als politiebureau en seinpost. Om de toren te beklimmen is het belangrijk dat je goed ter been bent. Er staat je namelijk een aantal smalle trappen te wachten.

Aanmelden
De wandeling is gratis en je hoeft je niet aan te melden.
Museum De Looierij
Het start- en eindpunt is bij Museum De Looierij
Aanvang: 14.00 uur.
Rondleidingen
Regelmatig organiseert Museum De Looierij gratis rondleidingen voor individuele bezoekers. Evenals wandelingen, waarin de geschiedenis van Dongen, centraal staat.
Het Museum is gevestigd in Kerkstraat 33 te Dongen. Je bent van harte welkom!
Wilt u van uw emotionele of angst problemen af?
Last van trauma of negatieve ervaring? Hypnose helpt!

Hypnose is een oplossing!
Voor
Hypnose kan eenoplossing zijn!
voor info:
email:info@hypnocura.nl
e-mail: info@hypnocura.nl


Marjolein Gerritsen
Telnr: 065478942
www.hynocura.nl
email:info@hypnocura.nl
Ze zijn zelf in het woonhuis naast het bedrijf gaan wonen en ze wonen hier nog steeds met veel plezier. Jan tuiniert het hele jaar door en geniet iedere woensdagmiddag van een ritje met paard en aangespannen wagen. Nelly is ook graag in de weer. Ze hebben een hechte familieband en komen met plezier bij elkaar met verjaardagen en andere gelegenheden.
Nelly en Jan hebben hun 60 jarig huwelijksjubileum gevierd met een mooie dienst in de kapel bij de zusters en met een gezellig feest.
Deze week presenteren wij jullie een foto welke gemaakt is in Dongen. Hoezo, waar dan, hoor ik jullie nu al zeggen. Laat ik jullie uit de brand helpen…de foto is gemaakt in een ruimte van een oude schoenenfabriek in de St. Jozefstraat: de JAL.
“De Schoenenfabriek J.A. Ligtenberg te Dongen was een Nederlandse schoenenfabrikant. Het door Huib Frankefort ontworpen rijksmonument de JAL schoenen fabriek (1924) is een icoon in het Brabantse dorp Dongen De onderneming begon in 1881 als handwerkbedrijf. Ze was opgericht door Johannes Antonie Ligtenberg. De productie omvatte aanvankelijk vooral zeelaarzen en vetleren werkschoenen die on-
Foto van de week

2e Pinksterdag
Maandag 29 mei
XXL
VLOOIENMARKT:
NAC STADION - BREDA

Adres: Rat Verleghstraat 2 4815 NZ BREDA
Echt een mega grote markt!
Particulieren zullen hier hun overtollige huisraad te koop aanbieden.
Zij zullen alles van de hand doen tegen scherpe prijzen.
WEG=WEG & OP=OP
Ook een standje huren??
KRAAMVERHUUR: INFO: 0161-456291
2E PINKSTERDAG
MAANDAG 29 MEI
Rat Verleghstraat 2 4815 NZ
KRAAMHUUR
VAN 10.00-17.00 UUR INFO: 0161-456291
Open Dag Scouting Laurentius
der meer in Rotterdam afzet vonden. Na enkele jaren breidde de onderneming haar assortiment uit met luxe herenschoenen. Rond 1900 vond de omschakeling naar het machinaal bedrijf plaats, gestimuleerd door Kees Ligtenberg. Naast Kees kwamen vervolgens ook zijn broers Janus, Piet, Henri en Antoon in het bedrijf te werken. In 1915 bedroeg de weekproductie ruim 2000 paren. Na de dood van de oprichter, in 1918, zetten de vijf gebroeders de zaken voort. In 1931 werd een bestaande plaats- en branchegenoot, schoenfabriek C & A Riemslag, overgenomen. Naast de schoenen onder het merk Jal werden hier jongens- en herenschoenen onder het merk Cowboy geproduceerd. Na de Tweede Wereldoorlog trad een derde generatie toe tot
de leiding. In 1956 werkten er 300 personen. In 1981 kon nog net het eeuwfeest gevierd worden voordat de fabriek haar deuren sloot.” (wikipedia) Sindsdien heeft de fabriek geen permanente bestemming meer gehad en is het gebouw in groot verval geraakt. In 2018 won Wenink Holtkamp Architecten, samen met opdrachtgever Hazenberg / Nico de Bont T.B.I. de tender voor de herontwikkeling van het gehele terrein. Ook het terrein heeft hoge cultuurhistorische waarde doordat het grenst aan het bijzondere landschappelijke Park De Bergen, een plek met bos en zandverstuivingen, midden in ons mooie dorp. Maar nu weer even terug naar de foto. De maker is Koos Schenk en werkt graag in zwart/wit. We zien een bijna symmetrisch op-
gebouwde foto van een trap met een witte roos. Die roos is daar uiteraard bewust neergelegd om iets extra’s aan de foto toe te voegen, hetgeen ik wel onderschrijf. Alleen over de plek waar je die roos weglegt kun je in discussie gaan: uit het midden en/of onderaan de trap. De maker heeft echter hiervoor gekozen. Binnen de club werd er ook nog gesproken over de betonnen pilaar boven de rechter trapzuil. Deze zou beter weg kunnen zijn en maakt de foto wellicht sterker. Misschien tijdens de opname over het hoofd gezien, maar in de nabewerking is dit niet al te moeilijk.
Koos, bedankt voor jouw foto. En dat nou juist iemand van buiten Dongen zo’n foto heeft gemaakt. Bent u geïnteresseerd? Neem contact op met Henk van Roode: henkvanroode@ziggo.nl
De prijswinnaars zijn bekend
‘Puzzel mee en maak kans op prachtige prijzen!’ Deze tekst sierde in week 17 de voorpagina van jouw weekblad. Een oproep die niet aan dovemansoren was besteed. Bijna 15.000 inzendingen ontvingen wij per post en mail.

Daarmee mag onze Koninklijke Voorjaarspuzzel een groot succes worden genoemd. De te winnen prijzen logen er dan ook niet om. Maar daarvoor moesten wel eerst de hersenen gekraakt worden. De krant moest van voor naar achteren… en weer terug doorgespit worden op zoek naar de specifieke adverteerder die op het geplaatste mini puzzelfragment betrekking had.
Dat viel nog niet mee. We ontvingen zelfs de nodige telefoontjes of ze er toch wel ècht allemaal in stonden. Daarin konden wij iedereen geruststellen en met een ‘Dan ga ik toch nog een keer zoeken’ werd meestal opgehangen.
Inmiddels zijn de prijswinnaars bekend. Zij krijgen spoedig bericht. Maar de hoofdprijswinnaar willen we hier natuurlijk niet onvermeld laten. Mariska Ophorst heeft de stedentrip voor twee personen ter waarde van € 1250,- in de wacht gesleept. Benieuwd welke stad zij gaat bezoeken. Gefeliciteerd Mariska en alle andere prijswinnaars.
Adverteerder Omschrijving prijs
Hoor je nu niet tot de gelukkige winnaars… in week 46 gaan we weer puzzelen. Dan staat onze Sintpuzzel in jouw weekblad. En ook dan zijn er weer heel wat prijzen te verdelen.
Naam winnaar
D-reizen retail HOOFDPRIJS - Stedentrip voor 2 personen t.w.v. € 1.250,- aangeboden door D-Reizen Mariska Ophorst
H3H Biennale 2 Toegangsbewijzen voor de h3h biennale Oosterhout t.w.v. € 17,50 p/stuk Susanne van Bragt
floor van Lieshout Progrestaart t.w.v. € 26,-
ETOS Dongen Cadeaubon t.w.v. € 35,-
Gert de Pee Optiek Cadeaubon t.w.v. € 35,-
Coco Bijoux & Cadeaux Cadeaubon t.w.v. € 35,-
Expert Oomen BV Cadeaubon t.w.v. € 50,-
RB Fietsen Cadeaubon t.w.v. € 35,-
Avri Kettle BBQ van Weber type E 4710 t.w.v. € 229,99
De Zaak van Geert Modecheque t.w.v. € 75,-

De Goeije Kroon VOF Cadeaubon t.w.v. € 15,-
DA Ingrid 3x Cadeaubon t.w.v. € 25,-
Slaapcomfort Het Zuiden BV 4x Cadeaubon t.w.v. € 25,-
Ton Kleemans
A. Kemmeren
JanSestig
Jacqueline Vink
Bianca Albinus
Henk Snelders
Rebekka ’t Hooft
Elleke Kimenai
Suzanna Haring
Martine de Jong
Roxanne Lankhorst
Open dag, maar dan anders. 13 mei was de open dag van Scouting Laurentius. Dit jaar geen traditionele open dag, maar een activiteit om vrijblijvend kennis te maken met het scoutingspel. Je hebt onze scouts wellicht door het dorp zien rennen en/of verstoppen met hun fluorescerende hesjes aan. Het spel: Hike en Seek. Het doel was om vanaf het startpunt ongezien ons scoutinggebouw aan Doelstraat te bereiken met zo veel mogelijk ’geld’ op zak. Geld kon je verdienen bij verschillende posten in het spelgebied. Werd je getikt door de ’seekers’,

dan moest je al je geld inleveren. Onze bevers, welpen, gidsen, verkenners, RSA, Pivo’s, Stam, vrijwilligers en bekenden hebben genoten van een heerlijke dag!
Na een lang en intensief spel hoefden onze leden niet zelf terug te lopen naar het startpunt. VANDERWOU was zo vriendelijk om ons terug te brengen, zodat iedereen weer met zijn eigen fiets naar huis kon. Lijkt scouting jou ook wat? Neem dan eens een kijkje op www.descouting.nl of stuur een e-mail naar lidworden@descouting.nl
Repaircafé ’s Gravenmoer
Op zaterdag 27 mei vindt in ’s Gravenmoer weer het repaircafé plaats. Tussen 10.00 en 12.00 uur kunt u langskomen in Dorpshuis De Geubel. Huishoudelijke apparatuur, laptops, printers, klokken, mobiele telefoons, kleding en sieraden: onze specialisten zijn aanwezig om u verder te helpen. Zij gaan weer aan de slag om uw spullen te repareren of om advies en handige tips te geven. En als er onderdelen moeten worden besteld, willen zij u daar graag bij
helpen. Er is meer mogelijk dan u denkt! Alle reparaties worden gratis uitgevoerd maar om de kosten te dekken zijn wij blij met uw vrijwillige bijdrage. Wij gunnen uw oude spullen een tweede leven. Ons motto is niet voor niets: “Weggooien? Mooi niet!!”
Tot ziens op 27 mei in Dorpshuis De Geubel in ’s Gravenmoer. De koffie staat klaar!! Het Repaircafé ’s Gravenmoer is een initiatief van Stichting De Geubel.

































































































Terugkijken op de Caraïben
Mijn dochter Bonnie (43) en haar man Dennis (40) zijn met mijn kleinkinderen Aaron (10) en Lianne (9) op wereldreis met hun zeilschip Enna, en zeilen een rondje Atlantische Oceaan. Ze naderen St Maarten, de laatste stop voor de grote oversteek naar de Azoren.

DOOR RUTH WILMANS
Sinds ze uit Suriname vertrokken, vaart de Enna door het oostelijk Caraïbische gebied, een sliert van eilanden die uitkijken op de Atlantische oceaan oostelijk van hen. Het loopt van Trinidad tot de Bahama’s. Inmiddels hebben ze zo’n vijftien grote en onbewoonde mini eilandjes aangedaan. Van Grenada, Saint Vincent en de Grenadines, Martinique, Dominica, Guadeloupe, Antigua, Barbuda en heel wat kleine eilandjes, totaal een 15 tal. Ik vraag Bonnie om eens terug te kijken op de topgrafie en de sfeer van de eilanden.

Weelderig
“We varen van zuid naar noord. De zuidelijke eilanden zijn heel oerwoudachtige eilanden met dikke bossen en bergen, maar zonder veel strand. Naarmate dat je noordelijker komt ga je verder van de evenaar af en wordt het droger en met lagere begroeiing. De standen worden wel mooier, maar de eilanden zoals Barbuda zijn in het binnenland bijna woestijn. Het interessantste vind ik de eilanden halverwege, een combinatie van bossen met strand en helder water, zoals Dominica. Dat eiland is zo mooi en weelderig en heeft een prachtig strand om te snorkelen. Wat wil je dan nog
meer? Je kunt lekker aan boord blijven of de zee in gaan, maar ook op excursie in de natuur van het eiland.
Pirates
We gingen op Dominica naar de Indian River, dat is de rivier die in de baai uitmondt. Het gebied daarachter is beschermd natuurgebied. We varen al roeiend het binnenland in. Onze gids vertelt uitgebreid over natuur, planten, dieren en de geschiedenis van Dominica. Het is een heel mooi idyllisch mangrove gebied waar we door heen varen. Het is werkelijk prachtig. Uiteraard hebben ze deze plek gekozen om een scene op te nemen voor de film Pirates of de Caribbean. Het hutje waar Jack Sparrow de heks bezoekt, wordt voor de toeristen goed in ere gehouden.

Oorspronkelijk gezag
De Caraïben zijn allemaal aparte landen. Soms zijn ze nog onder westers bestuur. Ze zijn dus niet verbonden door nationaliteit, taal of een munt. Wat hen bindt is de locatie en het klimaat. Van oorsprong leefden hier dezelfde inheemse volkeren; de Cariben, die er woonden ten tijde van Columbus. Later kwamen de kolonisten die er de tot slaaf gemaakten uit Afrika naar toe brachten om sla-
van de heks uit Pirates of the Caribbean.
venarbeid te doen. Qua cultuur hebben de eilanden wel veel met elkaar te maken, met wat nuance verschillen, afhankelijk door wie het gezag uitgevoerd werd en wordt.
We merken dat de eilanden waar de Engelsen lang de baas zijn geweest, zoals Grenada, behalve dat ze links rijden, trots zijn op hun onderwijssysteem. De Franse eilanden zoals Martinique, zijn wat meer gericht op een goeie infrastructuur. Bij de eilanden die al wat langer niet meer in bezit zijn van een westers land, is de organisatie van zo’n land minder sterk. Dat merk je in de voorzieningen en de wegen die slechter onderhouden zijn. De cultuur is daar niet zo op gericht. De bevolking van deze eilanden is wel meer ontspannen, ze leiden een laid back life.
Zelfredzaam
eiland waar het grootste deel van de bewoners goed verdient. Een eiland als Antiqua ziet er super chique en georganiseerd Engels uit. Maar als je het binnenland ingaat dan zie je de bouwvallige hutjes. Meerdere eilanden van St Vincent zijn echt arm. Over het algemeen moeten de eilanders het met heel weinig doen. Dat maakt hen wel heel zelfredzaam. De community zorgt voor eigen fruit en eten en ze benutten min of meer de mogelijkheden die ze hebben. Op sommige plekken slaan ze de handen ineen en denken slim na, hoe ze kunnen gebruik maken van de toeristen. Op een andere plek, soms maar een baai verder op hetzelfde eiland, krijgen ze het niet voor elkaar.
Conclusie
Tyrell Bay, een mini eilandje.
Kunst op de Biezenkring
Op maandag 15 mei ontvingen alle kinderen een toegangskaart voor het Biezenkringmuseum. Dit museum zou de komende dagen door henzelf worden ingericht. Hierbij zijn we enorm blij geweest met de hulp van ouders en met de input die we van het kunstpodium hebben gekregen.
Groep 1-2 heeft zich gericht op schilder- en tekenkunst. Zij kregen een geweldige workshop van Niels Ballemans en Stijn Rompa. De kinderen mochten met behulp van reuzelange stiften al bewegend over een groot doek een kunstwerk maken. Deze work-


shop sloot perfect aan bij het probleem waar de kleuters mee te maken kregen; ``Hoe kunnen we een kunstwerk in het platte vlak maken met verf en papier, wanneer we geen scharen en kwasten hebben?” De kinderen kwamen met goede oplossingen
Bij alle eilanden is er óf heel veel armoede, óf een heel groot verschil tussen arm en rijk. Er is geen
en na eerst met allerlei materialen te experimenteren ontstonden er prachtige kunstwerken. Sommige kregen zelf een naam en natuurlijk werd op ieder werk de naam van de kunstenaar vermeld.
In groep 3-4 stond bouwkunst centraal en werd er rond een zeer actueel onderwerp gewerkt. De kinderen mochten namelijk meubels ontwerpen voor hun nieuwe school. De kinderen ontdekten eerst hoe ze een stevige constructie konden bouwen met behulp van stokjes en stukjes pvc

Als toerist heb ik enorm genoten van al die verschillen. En terwijl jullie in de aanhoudende kou waren, hebben wij hier wel uitbundig genoten van het warme klimaat en de heerlijke zee.
buis. Daarna werden er met behulp van hout, karton, playmais etc hele functionele prototypes ontworpen die ook geschikt waren om in een kleinere ruimte te plaatsen.
Groep 5-6 hield zich bezig met de kunstvormen dans en muziek. Er werd een hele passende workshop georganiseerd door Janneke De Loey, waarbij de kinderen hebben ervaren dat je ook zonder taal en woorden te gebruiken kunt communiceren. Dit was ook het uitdagende probleem
waar ze deze themadagen mee aan de slag gingen: “ Hoe kan ik communiceren zonder woorden te gebruiken?” Andere oplossingen die werden bedacht door hen waren dans, mimespelen, dramatiseren en het uitbeelden van een “tableau vivant”.
De leerlingen van groep 7-8 hebben kennisgemaakt met MODE als vorm van Kunstuiting, duurzame mode en alternatieven
voor: “Wat als er geen stof meer gemaakt wordt?”
Na een bezoek aan de Eagle Shel-
ter in Dongen zijn er kleren geruild (of meegekregen) om hier een andere look aan te geven. De kinderen hebben een ontwerp gemaakt en met dank aan begeleiders (vaak met een naaimachine) werd in een naaiatelier op school het bedachte ontwerp uitgewerkt tot een eigen, nieuw kledingstuk.
Al deze Kunstwerken zijn woensdag tentoongesteld in ons Biezenkringmuseum en de opkomst was groot! De kinderen vertelden dan ook vol trots wat ze de afgelopen dagen
Pas op het zonneke schijnt
Teek


Ongevaarlijk meikevers.
Eindelijk daar is hij dan de zon, we kunnen er weer op uit, te voet, met de fiets enz. Veel mensen zoeken de natuur op, even er lekker tussen uit, wandelen in alle rust. Toch is er een waarschuwing op zijn plaats, want ook in de natuur schuilen allerlei gevaren en dan heb ik het niet eens over de wolf. Nee er zijn enorm veel kleine gevaren, eigenlijk veroorzaakt door ons als mens. Zon dat betekent dat men de mouwen opstroopt, of helemaal weg laat, de korte broek gaat aan, de rokjes worden korter. Mooi om te zien, tenminste soms, maar pas op, er loert van alles in de natuur. We beginnen maar bij de gewone mug, de minst gevaarlijke vijand, maar ook die kan lastig zijn.
Mug Muggen zwermen rond je heen, zeker op plekken met stilstaand water en dat zijn er juist nu best wel veel. Sloten, kleine poeltjes, vennen, daar wemelt het van de
muggen. In water leggen ze nu eenmaal hun eitjes, daaruit komen in water levende larven.
Tot op dit moment nog geen bedreiging, maar dan komt het
moment dat die larven het water verlaten, in de vorm van een mug. De mannetjes daar heb je niets van te duchten, maar de vrouwtjes, dat zijn de boosdoeners. Al snel na het uitkomen paren de
muggen en raken de vrouwtjes zwanger en krijgen ontzettende honger. Kom jij met je blote benen, armen en hals in de buurt, dan ben je een gemakkelijk doel. Ze vallen aan, prikken en zuigen je bloed op, om dat gemakkelijker te maken spuiten ze wat bloedverdunner in jouw lijf. Gevolg een jeukende plek, dus krabben en dat maakt het alleen nog maar erger. Gelukkig trekt de bult vrij snel weer weg.
Er wordt best wel vaak voor gewaarschuwd, voor dat enge kleine beestje, in hun beginstadium een speldekop groot. Teken houden zich op in wat langer gras, lage struikjes als heide, ze zitten daar te wachten op een voorbijganger. Bij muizenholletjes, konijnenholen en allerlei andere ingangen zitten deze teken graag. Ze wachten tot er een dier langs komt en bespringen deze dan en slaan toe. Ook de teek is het te doen om bloed, daar zitten immers veel bouwstoffen in. Teken voeden zich daarmee en planten zich snel voort. Om het bloed op te kunnen zuigen spuit ook de teek een soort van bloedverdunner in. En daar zit het gevaar, veel teken zijn besmet en dan kan een dergelijke tekenbeet leiden tot een ziekte. De ziekte van Lyme. De ziekte van Lyme wordt veroorzaakt door de bacterie Borrelia burgdorferi.. De teek wordt besmet als hij bloed zuigt bij kleine (knaag)dieren of vogels die de bacterie bij zich kunnen dragen. Wanneer een teek later bloed van mensen zuigt, kan de bacterie op de mens overgedragen worden. Ongeveer 1 op de 5 teken draagt de bacterie bij zich. De klachten lopen uiteen van spier en gewrichtsklachten, maar ook kan men hartproblemen ondervinden. Dus na een bezoek aan de natuur controleer uw lichaam op kleine zwarte beestjes en verwijder ze met een tekentang..

Bijen
De bij kennen we allemaal wel en dat hij kan steken met zijn angel weten de meesten ook. Toch is niet elke bij een gevaar, er bestaan immers vele soorten bijen. De honingbij is een geduchte vijand, welke behoorlijk kan steken. Bij een steek in de mond of keel: Bel direct 112. Laat het slachtoffer ondertussen op een ijsblokje zuigen om de zwelling tegen te gaan. Bij een allergische reactie: Bel direct 112 bij allergische verschijnselen na een bijensteek. Denk daarbij aan hevige benauwdheid, shockverschijnselen of een zwelling in de nek. Heeft het slachtoffer een adrenalinepen (EpiPen) bij zich? En heeft het slachtoffer gezwollen lippen of benauwdheid? Dan kun je hem of haar helpen om die pen toe te dienen. De adrenaline kan door de kleding worden toegediend als deze niet te dik is.
Dit doe je in overige gevallen: Schraap de angel weg met je vingernagel of de botte kant van een mes. Koel de plaats van de steek met een nat kompres of een coldpack. Gebruik zo nodig een zalf tegen de huidirritatie. Ga naar een huisarts als de steekplaats erg dik wordt.
Wespen De meest bekende is natuurlijk de wesp, in de natuur niet eens zo lastig. Echter in de tuin en op het terras wordt dat een heel ander verhaal. Ze zijn gek op allerlei zoetigheid, maar lusten ook een wijntje en biertje. Laat dat nou vaak op tafel staan tijdens uw zonne-uurtje. Eigenlijk gelden hier bij een steek dezelfde regels als bij een bij, alleen hoef je geen angel te verwijderen, simpelweg omdat de wesp geen angel heeft. Allerlei wespen komen er voor, gelukkig niet allemaal even lastig. De hoornaar bijvoorbeeld zal zelden steken, of hij moet echt in gevaar komen. Wordt je meermalen gestoken door een hoornaar blijf dan voorzichtig en volg dezelfde richtlijnen als bij de bij. Wespen zijn net als alle insecten erg nuttig, ze zorgen voor bestuiving, maar ze bestrijden ook plagen van andere insecten, dat doen ze door hun eitjes in die insecten te leggen, welke daardoor vanbinnen opgegeten worden.



Bloot
Veel leed kan worden voorkomen, door de juiste kleding, zeker als u de natuur in gaat. Draag zoveel mogelijk kleding, die de kwetsbare lichaamsdelen bedekt. Struin niet tussen struiken door, kortom blijf zoveel mogelijk op paden. Doe zeker geen lekkere geurtjes op, misschien leuk om aantrekkelijk te zijn, maar weet ook de lastige insecten ruiken u beter. In de handel zijn allerlei middeltjes om uzelf minder aantrekkelijk te maken en juist afstotelijk, voor muggen en dergelijke. Ook een hoofddeksel kan leed voorkomen, zeker bij het dragen van een hoed. Beestjes vallen op de hoed en rollen over de rand naar beneden en niet in uw nek. Broekspijpen die tot over uw schoenen reiken helpen ook tegen teken. Dus hoe minder bloot, hoe beter beschermd, blijf genieten, maar doe het veilig. Christ Grootzwagers, Natuurvereniging Ken en Geniet.
v.v. Olympia’60 3 viert kampioenschap
Na een reeks van twaalf gewonnen wedstrijden, leek er al een kampioensfeest in april gevierd te kunnen worden. Ware het niet dat puntenverlies in Oosterhout het feestje uitstelde. En dus werd er gekeken naar een mogelijke nieuwe datum. Dit zou dan een aantal weken duren, vanwege een paar vrije zaterdagen. Maar doordat de concurrentie verzaakte te winnen, was Olympia’60 3 al kampioen geworden zonder op dat moment zelf te spelen. En dus werd er een definitieve datum geprikt. Op 20 mei gingen ze met (bijna) de gehele spelersgroep en supporters in een partybus afreizen naar Goirle. Om daar om 17:00 uur te spelen tegen VOAB.

En wat een succes was dat. Het was prachtig weer en de stemming zat er goed in. VOAB stond met één punt behaald stijf onderaan in onze competitie. Het werd dus vooral een eenvoudige en gezellige wedstrijd. De tegenstander was op de hoogte van ons behaalde kampioenschap en speelde erg sportief. Ze gaven Olympia zelfs de optie om in de 2e helft dezelfde kant op te spelen als in de eerste helft. Zo konden de supporters de goals vanaf het terras bekijken. De doelpun -
ten makers in dit duel waren Sammy(1x), Kevin van Venrooy(4x), Chiel(1x), Carl(2x), Rowan(1x) en Lars van Loon(1x). Als je even mee hebt geteld, zijn dat inderdaad tien goals. VOAB lukte het niet om in de eerste helft te scoren bij gelegenheidskeeper Bryan. Maar zij scoorden nog wel twee ere treffers in de tweede helft bij keeper Chiel, die zelf in de eerste helft nog scoorde. Met deze mooie uitslag en drie punten,
HV Dongen on Tour in Heerhugowaard
De B en C meiden van HV Dongen hebben op Hemelvaartsdag deelgenomen aan een toernooi van handbal vereniging Tornado uit Heerhugowaard. In de middag was het de beurt aan de C van HV Dongen en in de avond was de B aan de beurt. De C opende tegen Nieuwegein, maar moesten er nog een beetje inkomen. Deze wedstrijd ging verloren. En ook tegen Schagen kwam Dongen tekort. Maar 6-2 winst tegen Tornado en winst tegen CSV (6-3) bracht Dongen weer wat omhoog in deze poule. Laatste wedstrijd was een spannende tegen KSV ook uit Heerhugowaard. Deze eindigde in een 7-7 eindstand waardoor HV Dongen op een mooie 3e plaats terecht kwam. Rond 19:00 was de B van HV Dongen aan de beurt. Die speelde 3 wedstrijden van 25 min. En de tegenstand was fors. Tegen KSV

Heerhugowaard ging het aardig gelijk op, maar was er toch een 1410 verlies. Tegen CSV uit Schagen werd Dongen een beetje overlopen en moest het doen met een 13-4 verlies. Laatste wedstrijd tegen Meervogels (Akersloot) was
weer meer in evenwicht. Maar winst zat er niet in. 8-6 in het voordeel van Meervogels. Maar rond half 10 werd na een lange dag het leuke toernooi afgesloten en kon Dongen aan de terugreis beginnen.
gingen Olympia weer terug naar Dongen in de kampioensbus.
Aangekomen bij Sportpark Crispijn, waren er gelukkig nog veel Olympianen aanwezig. Hierdoor kon het feestje, dat in de kleedkamer al was begonnen, doorgezet worden. Het derde ontving nog een mooie beker, een bosje bloemen en een clubkaart uitgereikt door voorzitter Corné Thomassen en secretaris Joyce Voskuil.
DVVC JO13 sluit seizoen af met eerste overwinning
De laatste wedstrijd van het seizoen moesten we tegen onze buren Olympia’60 JO13-2. Na de winterstop is dit team als JO13 op groot veld gestart, en dat is met vallen en opstaan gebeurd. Maar altijd met een positieve instelling om de wedstrijden te starten.
Soms kwamen we op voorsprong of trokken we de stand gelijk, om dan het laatste kwart nog de pot verloren zien te gaan. Tot afgelopen zaterdag hebben we 1x gelijk gespeeld en de anderen net verloren. We hadden ons voorgenomen om nog 1x alles te geven en 100% strijd te leveren zodat we zouden proberen het seizoen met een overwinning af te sluiten. Na een overtuigende openingsfase met al een aantal schietkansen was het na ongeveer 20 minuten dan toch raak. De eerste goal in deze wedstrijd komt op conto van DVVC. Het hele team was enorm blij en gemotiveerd om dit door te zetten. Ook al kwam Olympia ook geregeld gevaarlijk voor onze goal. Maar dan stond onze verdediging of de keeper zijn mannetje en werden de kansen teniet gedaan. Net voor de rust kreeg onze spits nog een mooie kans maar die werd door een Olympiaan goed geblokt. Rust 0-1.
Peptalk:
Na de peptalk om na de rust zo door te blijven gaan, vlogen we letterlijk uit de startblokken door in korte tijd 2x te scoren. Na die stand gooide Olympia alle schroom van zich af en gingen ook veelvuldig aanvallen. Dat leverde na 15 minuten een tegendoelpunt
GRAFISCH
Archieffoto: JO13 spelers actief tijdens andere wedstrijd.
op. Olympia kreeg weer hoop en bij DVVC gingen we twijfelen. Aanvallen of toch goed blijven verdedigen? Na nog een paar hachelijke momenten was het toch onze trefzekere spits die net voor tijd zijn derde maakte en zo konden we de eerste 3 punten mee naar huis nemen.
Een mooie teamprestatie. Zo zie je maar: Als je hard blijft werken wordt je vanzelf een keer beloond. Gefeliciteerd jongens en meisjes met deze mooie overwinning. Eindstand: 1-4. Dit was de laatste competitiewedstrijd, maar we gaan het seizoen in stijl afsluiten. Zoals met het Jan Smans Jeugd-mini-veldtoernooi! Vergeet niet om je -eigen samengesteldteam in te schrijven. En natuurlijk hebben jullie je al aangemeld voor het gezellige voetbalweekendkamp. We zien jullie dan!
TWEEDE HELFT COMPETITIE WINSTGEVEND




Dongen zaterdag gaat voor nacompetitie bij ONI
Het was afgelopen zaterdag een klein, maar toch, groot feestje. Na een onthutsend slechte eerste helft, waarin Dongen op alle fronten werd overklast door het inmiddels gedegradeerde Vuren, kwam de ploeg van trainer Luke van Overbeek als herboren na rust uit de kleedkamer. Heb je in de pauze de mannen toegesproken? “Ja dat kun je wel zeggen. Ik heb gezegd wat ik ervan vond en gezegd dat ze maar moesten kijken wat ze met deze woorden gingen doen. Ik ben toen direct de kleedkamer uitgelopen,” vertelt trainer Luke van Overbeek na afloop. Zijn ploeg had met de rust voor hetzelfde geld met 0-4 achter kunnen staan. Hij is duidelijk opgelucht dat zijn tirade vruchten heeft afgeworpen. Zijn ploeg trok de verantwoordelijkheid naar zich toe en boog de 0-1 achterstand binnen een kwartier om in een 4-1 voorsprong.
DOOR PIET SCHEEPERS
Vuren is een mix van jong en oud. Vijf spelers van nog geen 19 jaar en aantal routiniers moeten de toekomst van de club gaan worden. Dongen had duidelijk de eerst helft problemen met het spel van Vuren. Lange ballen, gedragen door de wind, naar voren werden soms problemen. Met name Jeroen Hultermans had het de eerste helft moeilijk tegen de snelle 18-jarige vleugelaanvaller Van der Vliet. Aan de ander zijde was de andere 18-jarige jongeling Mol die linksbuiten Timo van der Schans regelmatig tot verdedigen terug dwong. Dongen leed aanvallend veel balverlies door slordig spel. Dat kostte de thuisploeg in de 10e minuut de openingstreffer voor Vuren. Een diepe bal werd onderschat waardoor Paul Brent zijn inzet, langs doelman Tom van Strien vanaf de achterlijn, via de verre hoek binnen zag rollen. Vuren legde Dongen de wil op. De thuisploeg kon geen potten breken.
Na rust bracht Van Overbeek Floris van Dongen in de ploeg. Hij moest voor meer rust op het
kansen aaneenrijgen. In de 60e minuut werd Floris van Dongen onreglementair aangepakt in het vijf meter gebied. Scheidsrechter Nico Opstraat kon niets anders doen dan de bal op de 11 meter stip leggen. Voor Bas Jansens de mogelijkheid om ook zijn doelpuntje mee te pikken. Overigens floot deze scheidsrechter zijn 999e wedstrijd. “Ik hoop dat de 1000ste volgende week wordt, ONI tegen Dongen,” was voor de wedstrijd de wens van de man in
Toost op de goede afloop.
middenveld zorgen. Zoals gezegd kwam ook de ploeg herboren uit de kleedkamer. Maarten Waltman onderschepte in de 49e minuut de bal en stoomde op naar voren. Uit deze snelle aanval volgde een prima voorzet die op waarde werd ingeschat door Floris van Dongen. Hij nam de bal ineens op de slof en de gelijkmaker was daar. Even hiervoor had het ook 0-2 kunnen zijn doordat de centrale verdediging van Dongen niet alert ingreep. Nog geen drie minuten later werd Chivarno Pansa de diepte ingestuurd. Op zijn hard en laag schot had de forse doelman van Vuren geen antwoord. Dongen draaide de wedstrijd om naar 2-1 en bleef de
vv Dongen
Uitslagen
Dongen 1 - Vuren 1
Dongen O23-1 - Gemert O23-1
Dongen O23-2
het zwart uit Den Bosch. Ondertussen scoorde Saban Cemrek vanuit een scrimmage de 4-1. Dongen bleef aandringen. Van der Schans soleerde langs de lijn richting doelman Tim Ritmeester. Van der Schans kon deze blok beton niet omzeilen en zag zijn inzet via de doelman over de zijlijn gaan. Dongen wisselde door. Zo maakten Roman Talboom, Tim Oomens, Roland Snoeren, Jannik van der Pas hun opwachting. In blessuretijd was het Talboom die met de 5-1 de kers op de taart zette. Komende zaterdag de afsluitende wedstrijd in ’s Gravenmoer tegen ONI. Aanvang 14.30 uur. Afscheid van de trainers bij zowel Dongen als ONI.
OP ZOEK NAAR EEN (NIEUWE) BAAN?
Koninklijke Drukkerij
PERSBERICHT
Em. de Jong zoekt jou!
Privacyverklaring Secapp BV en Secapp Buizen BV
Ben jij onze nieuwe Els?
(verder genoemd als Secapp, we en wij)
(hulp in de huishouding - M/V)
Koninklijke
drukkerij Em. de Jong zoekt jou!
Administratief Medewerker Finance
Machine Operator
Ben jij nauwkeurig en houd jij van cijfers? Het is onder andere jouw taak om verkoopfacturen verzendklaar te maken, te ondersteunen bij de debiteurenbewaking en het gereed maken van betaalvoorstellen.
Heb je nog weinig ervaring in dit werkveld?
Geen probleem, we leren het je graag!
Ben jij op zoek naar:
Ben jij op zoek naar:
•Een uitstekend salaris?
• Een fulltime baan (32-40 uur) bij een bijzonder familiebedrijf
• Met ploegendiensten nog meer verdienen?
• Een team met enthousiaste collega’s en een informele werksfeer
• Zonder ervaring werken met de nieuwste technologie bij de grootste drukker van Europa?
• Aantrekkelijke arbeidsvoorwaarden
• Uitgebreide ontwikkelingsmogelijkheden?
• Werken in een geweldig team bij een gezellig familiebedrijf?
Bekijk al onze vacatures op werk.emdejong.nl
Privacy beleid
Onze Els gaat na ruim 27 jaar genieten van haar welverdiende pensioen. Al die tijd hield zij onze kantoren en overige ruimtes spik en span! Om die reden zoeken wij op korte termijn een nieuwe hulp.
Ben jij een optimistisch en flexibel persoon en weet je van aanpakken?
Dan zoeken we jou!
Het is een parttime baan (± 12 tot 14 uur) voor meerdere ochtenden per week. Interesse? Bel of app met Ryan Heusinkveld: 06 - 517 17 947.
Uw privacy is belangrijk voor ons bij Secapp. We gebruiken uw bedrijfs- en persoonsgegevens uitsluitend om uw account te beheren,onze producten en diensten aan u te leveren, en om u te informeren over deze producten en diensten, voor zover u hier toestemming toe heeft verleend. We hechten veel waarde aan de bescherming, vertrouwelijkheid en integriteit van uw gegevens. In deze privacy verklaring leggen we uit welke gegevens we van u verzamelen, hoe we deze gebruiken, hoelang we ze bewaren, hoe u uw persoonsgegevens kunt beheren en de wettelijke grondslagen op basis waarvan we uw gegevens verwerken.
Secapp Buizen B.V. • Florijnstraat 1-3 • 4903 RM OOSTERHOUT
Onze Diensten
Acquisitie n.a.v. deze advertentie wordt NIET op prijs gesteld.
Secapp is een allround Steeltrader gevestigd aan de Florijnstraat 1-3 te 4903 RM Oosterhout, Nederland. Geregistreerd bij Koophandel onder nummer: 20085587.

Wij handelen in staalprodukten uit productie overruns en verzekeringspartijen.
Welke bedrijfs- en persoonsgegevens worden verzameld?
We hebben bepaalde gegevens nodig om u de best mogelijke service te kunnen bieden en u te informeren over onze producten en diensten. Sommige gegevens geeft u ons direct, bijvoorbeeld als u per mail een offerte aanvraagt of bestelling doet. Daarnaast ontvangen we bepaalde gegevens indirect via bijvoorbeeld tips vanuit de markt. Hierdoor kunnen we onze diensten personaliseren en verbeteren. De volgende gegevens worden bij Secapp verwerkt:

- Bedrijfsnaam
- Vestigingsadres
- BTW nummer en KVK nummer (indien van toepassing)
- Telefoon- en faxnummer
- Emailadres en Website
- Contactpersonen met eventueel mobiel telefoonnummer en emailadres
- Eventuele betaal- en bankinformatie, zoals bankrekeningnummer
Website
Via onze website kunt u aanvragen doen voor bepaalde producten.
Bij gebruik van de website wordt uw IP-adres niet opgeslagen. Ook wordt er geen gebruik van Cookies
Hoe gebruiken we uw bedrijfs- en persoonsgegevens?
We gebruiken uw bedrijfs- en persoonsgegevens voor de volgende doeleinden:
Uitvoering van de overeenkomst
We verwerken de gegevens om aan u te leveren en te factureren.
Klantencontact en communicatie
Uw gegevens worden gebruikt om met u te communiceren via telefoon, e-mail en andere media.
Marketing
Hoogrendements
• Hoogrendements glas, enkel glas


Postzegel en Munthandel ‘Den Besterd’
Stoffeerderij van Hoorn Voor al uw meubelstoffeerwerk Bel voor een vrijblijvende offerte 06-19748242 www.stof feerderijvanhoorn.nl
• Afhalen, montage, glasreparatie
• Afhalen, montage, glasreparatie
in- en verkoop:
• Postzegels
• Lekke ruiten vervangen
• Lekke ruiten vervangen
• Munten
• Goud
GEVRAAGD:
• Glazen tafelbladen
• Glazen tafelbladen info@buijsglashandel.nl

info@buijsglashandel.nl
Vennen 57 • Dongen
• Zilver
Open do-vr-za 9.00 - 17.00 u Besterdring 54 • Tilburg
Telefoon: 0162 - 314 012
Vennen 57 • Dongen Telefoon: 0162 - 314 012
Tel.: 06 14 02 71 77 denbesterd54@gmail.com
De Witte Onderhoud Voor al u schilder & kluswerk binnen/buitenshuis. U kunt vrijblijvend een offerte aanvragen. Heeft u interesse, neem dan telefonisch contact op 0683353504 of email; klusbedrijf.dewitte@hotm ail.com
We willen u graag via e-mail en telefoon op de hoogte houden van onze producten en diensten. U om zich te allen tijde af te melden voor deze informatievoorziening, per e-mail of per telefoon.
CARAVANS
Oude metalen, sloopauto’s, accu’s, fietsen, caravans, brommers, scooters, aanhangers, enz.
THEMA-WANDELING op zat 27 mei in Mastbos. Aansluitend koffie/thee op leuk terras. Kom je ook? Aanmelden/info: moniquevandelaar.nl/vrou wen-power-cirkel/ of 0627401365.
Veiligheid, beveiliging en beslechting van geschillen
www.vangompelzonweringen.nl Actie zonweringen en rolluiken tel. 0416-361575 Ook voor uw screens, hordeuren, garagedeuren, markiezen en raamdecoratie.

GEVRAAGD met SPOED & Campers à contant of per bank!
In voorkomende gevallen kunnen we gegevens gebruiken in het kader van geschillenbeslechting, om van een overeenkomst met u af te dwingen, om onze rechten te beschermen of onszelf te verdedigen vorderingen en/of beweringen van derden.
Bel: 06-31054041
Laptop traag? Virus,data kwijt, of andere computer hulp nodig? Gewoon aan huis/bedrijf. Email naar info@cloudeurope.nl of bel met 06-14178330.
Secapp BV en Secapp Buizen BV Florijnstraat 1-3 4903 RM OOSTERHOUT
Voor elke klus, verbouwing,renovatie of schilderwerk in deze regio, bel LOODS22 06-24899490. Kwaliteit voor een betaalbare prijs. www. loods22.eu
Jos Hommel Caravans Heistraat 143-145
Sprang-Capelle 0416-274672 06-23633117
Nature Dinner Cruise
Uit eten op het water met ons nieuwe schip Z9
• Culinair genieten in de Biesbosch
Wil jij extra bijzonder uit eten? Stap aan boord van ons gloednieuwe schip Z9 en geniet samen met familie, vrienden of collega’s van een heerlijk buffet en dessert. Tijdens deze cruise varen we dwars door Nationaal Park de Biesbosch.

Volwassenen:
€ 59,50 p.p.
Data: 27, 28 en 29 mei, 4, 10, 11, 18 en 25 juni, 8 juli, 20 augustus, 3 september
Uitgebreide voorgerechten, buffet en uitgeserveerd dessert.
Duur van de tocht: 3 uur (starttijden verschillen per dag)
Rondvaartbedrijf Zilvermeeuw
Biesboschweg 2, 4924 BB Drimmelen I 0162-682609
www.zilvermeeuw.nl I info@zilvermeeuw.nl
COMPETITIE UITSLAGEN
Bridge 82
Donderdag 11 mei
A lijn
1. Gerry Pieren & Ton Kleemans
2. Marian Lenaerts & Regina Langeveld 55,95%
3. Gerda Meijerink & Gijs Pieren
1. Plony Rommelse & Jan Kersbergen
2. Cees Nanning & Peter Nanning
3. Ellie van Beijsterveldt & Loek van der Heide 56,77%
lijn
1. Sjan de Kort & Frans van Boxel 64,17%
2. Joke de Lizer & Wil van Elsen 62,08%

3. Jan van Beijsterveldt & Jeanne van Riel 56,25%
Dinsdag 16 mei
A lijn
1. Maria van Braband & Elly Kimenai 65,83%
2. Marjan van Tooren & Joke Verbiest
Marian Lenaerts & Fanny van Dun
3 Ton van Tilburg & Martien Trommelen
1. Loek van der Heide & Jeanne van Riel
2. Wil van Elsen & Greet Vermeulen
3. Berty Spruijt & Bob Spruijt
1. Ingrid Graat en Madeleine Ruttchen
2. Anny van den Heijkant & Pie Ruttchen
3. Marijke den Hartog & Peter den Hartog
Bridge voor senioren
1. dms. C.Brugman - C.
2. mevr. H.
Dongense Biljart Bond
Willem II wil via VVV naar volgende ronde
Voetbalminnend Tilburg en omstreken kijkt uit naar zaterdagmiddag 16.30 uur. Dan speelt Willem II in het eigen Koning Willem II stadion de terugwedstrijd van de eerste play-offronde tegen VVV-Venlo.

Deze voorbeschouwing is aangeleverd vóór de heenwedstrijd van dinsdag 23 mei.
Mondhygiëniste Dongen nieuwe sponsor Atledo



Ilona en haar zoon zijn beide lid van Atledo en dit was voor haar een directe reden om iets terug te doen voor de club. Atledo is een prachtige vereniging waar mijn zoon en ik ons prima thuis voelen. De sfeer binnen Atledo is goed en iedereen wordt gewaardeerd. Daarom wil ik Atledo graag sponsoren. Natuurlijk is het ook leuk dat ik iedere keer langs mijn eigen reclame loop lacht Ilona. Atledo is heel blij met de sponsoring.
Ilona Evers is eigenares van Mondhygiëniste Dongen. Haar praktijk heeft zij aan huis in de Jeroen Boschstraat 4 in Dongen.
Willem II verzekerde zich weken geleden al voor deelname aan de play-offs. Promotie via die play-offs is de aangepaste doelstelling nadat gaande het seizoen duidelijk werd dat nummers 1 en 2 PEC Zwolle en Heracles Almelo, die direct promoveerden, uit het zicht raakten.
In aanloop naar de allesbeslissende fase van het seizoen is Willem II al tien wedstrijd op rij ongeslagen. Zeven van die tien werden gewonnen, maar door het gelijke spel tegen Roda JC afgelopen vrijdag werd op de valreep de periodetitel verspeeld.
Dankzij een zege en twee gelijke spelen in de laatste drie competitiewedstrijden garandeerde VVV-Venlo zich van deelname aan de play-offs. Daarvoor werd voor het laatste op 13 maart gewonnen. Van een blakende vorm van de Venlonaren is dus geen sprake. De winnaar van het tweeluik Willem II – VVV Venlo treft de winnaar van Almere City FC – FC Eindhoven. Die eerste wedstrijd is op 30 mei.
Kijk voor meer informatie over de ticketverkoop van Willem II – VVV op www.willem-ii.nl.
TICKETSHOP.WILLEM-II.NL

Onder wi jshelden opgelet!
Ben jij op zoek naar een nieuwe uitdaging binnen het basisonderwijs?
VACATURES WILLEM VAN ORANJE SCHOLENGROEP:
SBO De Leilinde, Oudheusden
- Leerkracht onder- en middenbouw
- Leerkracht IJsberen
- Leerkracht (uitstroom)groep







Juliana van Stolbergschool, Waalwijk

- Leerkracht middenbouw
De Bron, Sprang-Capelle
- Leerkracht (met aanvullende taak als intern begeleider)
Koningsschool, Waalwijk
- Creatieve leerkracht

Bekijk hier ons actuele
Interesse? Bezoek onze website: www.willemvanoranjescholengroep.nl/ werken-bij-onze-scholengroep
Samen staan we sterker
Tijdens het werven van nieuwe collega’s bundelen wij, als christelijke basisscholen in de regio, onze krachten. Samen staan we sterker en kunnen we van betekenis zijn in jouw zoektocht naar een mooie baan binnen het onderwijs.
VACATURES DE STROMING:

CBS De Zaaier, Andel
- Leerkracht groep 1/2
- Leerkracht groep 8
CBS Het Fundament, Genderen
- Leerkracht middenbouw
CBS De Regenboog, Nieuwendijk
- Leerkracht cluster 2 of 3

CBS Het Baken, Werkendam
- Leerkracht onderbouw
CBS ‘t Kompas, Werkendam
- Intern begeleider
Interesse? Bezoek onze website: www.destroming.eu/vacature
530 KM VOOR HET GOEDE DOEL ROPARUNTEAM ’T HALVE ZOLENLIJNTJE GAAT ER WEER VOOR!
Voor de vijftiende keer maakt ‘t Halve Zolenlijntje zich op om deel te nemen aan de langste non-stop estafettewedstrijd ter wereld, de Roparun. Op zaterdag 27 mei staan ze aan de start in Enschede. Na 530 km continu lopen, hopen ze op maandagmiddag 29 mei op de Coolsingel van Rotterdam te finishen. De Roparun is een groots evenement, opgezet om kankerpatiënten en hun familie in een heel moeilijke periode van hun leven te ondersteunen.
DE MOTIVATIE
Roparunteam ‘t Halve Zolenlijntje is een team van 26 enthousiaste en sportieve dames en heren dat een dubbele uitdaging is aangegaan. Al in 2006 werd deze groep gegrepen door de formule van de Roparun. De meeste leden kwamen toen uit dorpen die liggen aan het vroegere Halve Zolenlijntje. Dit verklaart deels de naam van het team. Verder loopt het als een trein bij deze groep en voelen ze zich vaak halve zolen als ze denken aan de inspanningen die gedaan moeten worden. De laatste jaren eindigde dit team zelfs vaak in de top tien in deze monstertocht. Ze zijn er zeker van dat ze ook nu het doel gaan halen. Op het sportieve vlak moet een uitgekiend trainingsschema ervoor zorgen dat alle ambities waargemaakt kunnen worden.

Ook is er terdege nagedacht over het opzetten van de organisatie van deze operatie. De motivatie voor al deze inspanningen komt voor-
al voort uit de waardering die het team heeft voor de doelen die de landelijke Roparunorganisatie gesteld heeft.
HET DOEL
Het motto van de Stichting Roparun is: “Leven toevoegen aan de dagen, waar vaak geen dagen meer kunnen worden toegevoegd aan het leven”. Het doel van stichting Roparun is geld bijeen te brengen ten behoeve van het fantastische werk dat gedaan wordt voor de kankerpatiëntjes die behandeld worden in het Sophia Kinderziekenhuis en de Dr. Daniël den Hoed Kliniek in Rotterdam. Enkele andere voorbeelden van met de sponsorgelden gerealiseerde doelen: de aanschaf van vakantiebungalows, waar kankerpatiënten en hun familie, ver van alle beslommeringen, grote dramatische veranderingen in hun leven kunnen verwerken, een project thuiszorg voor terminale kankerpatiënten, hospices, inloophuizen,
hoofdhuidkoelers. Palliatieve zorg in de breedste zin van het woord. Dit jaar konden er ook lokale doelen gesteund worden. Doordat Dongen in 2022 de derde plaats had gewonnen in het klassement van beste Doorkomstplaatsen kon ’t Halve Zolenlijntje Hospice Dongen en het project Poppy’s komt naar Dongen financieel ondersteunen.
26 SCHAKELS, 1 TEAM
Acht atleten gaan zo snel mogelijk de afstand tussen Enschede en Rotterdam hardlopend overbruggen. U zult begrijpen dat 530 kilometers hardlopen niet zomaar volbracht kan worden. Drie chauffeurs, twee kaartlezers, vier fietsers, drie masseurs, drie koks en drie teamcaptains vormen samen het team om deze uitdaging te kunnen aan gaan. Alle schakels zijn even belangrijk. Maar er is nog meer nodig: drie bussen, een mobiele keuken, mobiele stroomvoorziening, massagetafels, een koelkast, fietsen enz., enz.. Ze trainen al maanden vrijwel dagelijks volgens individuele schema’s. Als team werd overdag en ’s nachts geoefend. Het leverde een op elkaar ingespeeld team op.
SPONSORACTIVITEITEN
Dit team ziet het als een grote uit-
daging om zoveel mogelijk sponsorgelden bijeen te brengen voor dit meer dan sympathieke doel. Er werden heel wat lootjes en andere zaken voor het goede doel verkocht. In november/december was er de actie Sint en Piet aan huis. In maart organiseerden ze de Halve Zolentrail met een meer dan fraaie opbrengst. In Dongen werden Miniroparuns voor kinderen georganiseerd.
Het team verleende haar assistentie aan evenementen zoals de Mountainbiketoertocht “The Cross for the Crocus” en de hardloopwedstrijd “De Kaaienloop” in Oosterhout en aan het Oranjeparkfestival in Dongen. In ruil voor deze hulp doneerden deze organisaties een mooi bedrag aan het team.

Verder zoekt het actieve Roparunteam naar sponsors uit alle sectoren en van allerlei formaten. Op de site van het team, www.halvezolenlijntje.nl kunt u lezen welke tegenprestaties en reclamemogelijkheden geboden worden. Het Roparunteam met startnummer 86 garandeert dat de sponsorgelden voor de volle 100 % ten goede komen aan het goede doel.
UITZWAAIEN
Op zaterdag 27 mei om 10.30 uur kunt u het team uitzwaaien. Ze vertrekken vanaf de Klein Dongenseweg 67 in Klein Dongen. U kunt hun oranje tenue niet missen. Loopt u ook warm voor het Roparundoel, kom dan in beweging en ondersteun ‘t Halve Zolenlijntje!

CONTACTGEGEVENS
VAN
Hertog Janstraat 41

5104 EX Dongen www.atledo.nl
’T HALVE ZOLENLIJNTJE BEDANKT DONGEN
Dongen heeft er met de doorkomst van de Roparun een evenement bijgekregen. Iedereen kan begrijpen dat een evenement van een dergelijke omvang niet zonder de hulp van velen gerealiseerd kan worden. Dongen heeft laten zien waarin het goed is: een evenement dragen met vele partners en zo tot een succes maken.
DANK AAN ALLE VRIJWILLIGERS
Roparunteam ’t Halve Zolenlijntje wil hier dan ook graag alle vrijwilligers bedanken. De samenwerking met AV Atledo, de Dongense horeca en burgemeester en wethouders is voor ‘t Halve Zolenlijntje niet alleen hartverwarmend, maar ook essentieel.

Ringbaan-West 328
5025 VB Tilburg www.luxemborg.nl
Regie Op Loopbaan Welke ROL pak jij?
Veldstraat 22
5104 EL Dongen www.regieoploopbaan.nl
In het weekend dat het complete Roparunteam onderweg is, bouwen vele vrijwilligers het feestterrein op en ook ’s avonds ligt de hele logistiek en bemanning van alle posten in handen van Atledo. De hele Roparun kan deze mensen niet genoeg bedanken.


Burgemeester en Wethouder verlenen ook hun medewerking aan dit festijn. Zij zullen aanwezig zijn om de doortrekkende teams toe te juichen, maar zij helpen ook bij het jureren, bij de bediending en zijn betrokken geweest bij het verlenen van vergunningen en de p.r.
Langs de route zullen verschillende horecaondernemers hun terrassen versieren, muziek laten horen en zorgen zo voor een gastvrije en feestelijke sfeer voor de voorbijtrekkende teams. ’t Halve Zolenlijntje is ook heel trots op alle artiesten die belangeloos gaan optreden in de feesttent.
DANK AAN DE SPONSOREN
Maar niet alles kan gratis gebeuren. De grote feesttent, het podium, licht en geluid kosten nu eenmaal geld. Geld dat niet onttrokken mag worden uit de kas van het Roparunteam. Dit geld is namelijk verzameld voor het goede doel en gaat daar ook in zijn geheel naar toe. Daarom is ‘t Halve Zolenlijntje ook zo blij dat zij vele sponsoren gevonden heeft die het financiële deel van het doorkomstfeest mogelijk maken. De dank gaat dus uit aan alle adverteerders en aan de hoofdsponsors!
Veldsteen 36
4851 PK Breda www.elines.nl
Café d’Ouwe Sok
Tramstraat 60 - Dongen - Tel. 0162-312006
Belgielaan 2a

5101 ZG Dongen www.salamanderdongen.nl
MDMVERHUUR
Voor al uw feestbenodigdheden springkussens etc. Dennis van den heijkant 06-40174224 info@mdmverhuur.nl www.mdmv erhuur.nl
Vaartweg 34 5106 ND Dongen ww.mdmverhuur.nl
Industrieterrein Tichelrijt Steenstraat 9 5107 NE Dongen Tel: + 31 (0)162 31 4944
Beste Dongenaren,
Op 1e pinksterdag gaat het weer gebeuren. De Roparun komt ook dit jaar weer door Dongen. Dat we in Dongen van een goed feestje houden is inmiddels wel bekend. Daarom wil ik alle Dongenaren oproepen om huizen en straten te versieren. Kleur Dongen oranje, de kleur van team ’t Halve Zolenlijntje. Geef hun en alle teams een heel hartelijk Brabants welkom.
Laten we ervoor zorgen dat de teams hier, door ons Dongens enthousiasme, een fantastische ervaring krijgen.
De teams lopen voor het goede doel: de palliatieve zorg voor kankerpatiënten.

Als ik dit schrijf is er inmiddels al ruim €1.850.000,opgehaald en de teller loopt nog steeds op. Daar doen onze teams het voor en uw aanmoediging is daarbij enorm belangrijk!

Langs deze weg wil ik de teams heel veel succes wensen. Bedankt sponsoren, organisatoren, muzikanten, horeca ondernemers, alle vrijwilligers en atletiekvereniging Atledo, dankzij jullie inzet wordt het weer een fantastisch feest. Jullie maken er weer een prachtig evenement van.
Dongenaren, kleur Dongen oranje en laat van je horen! Hup team ’t Halve Zolenlijntje!
Marina Starmans- Gelijns Burgemeester gemeente Dongen

ORANJEFEEST BIJ DOORKOMST ROPARUN
Wanneer de Roparun aankomende zondag 28 mei door Dongen komt, zal dit niet onopgemerkt blijven. De route komt namelijk binnen bij Dongen Vaart, gaat dwars door het centrum en verlaat onze gemeente pas weer via de Eindsestraat op weg naar Tilburg. Vergeleken met vorig jaar loopt de route dus nog meer door het centrum (Hoge Ham, Prak Vredeoord, Looiersplein, Tramstraat). Daarnaast trekken de begeleidende voertuigen ook nog door de Gasthuisstraat en de Kardinaal van Rossumstraat.

AANMOEDIGEN IN HET ORANJE
De deelnemers aan de Roparun, die zich zo intens inzetten voor het goede doel, verdienen het natuurlijk om luidkeels aangemoedigd te worden. Hopelijk staan er dan ook vele toeschouwers langs de route te juichen. Maar zou het niet leuk nog een stapje extra te zetten en ook woningen, tuinen en bedrijven te versieren. Bij voorkeur in het oranje; de kleur van het teamtenue van ‘t Halve Zolenlijntje.
Bovendien is oranje een makkelijke kleur. Op Koningsdag kleurde Dongen immers ook al behoorlijk oranje. Laten we dit met zijn allen nog eens dunnetjes overdoen. Voor het mooiste en meest uitbundig versierde pand wordt zelfs een prijs uitgereikt. De jurering hiervoor is in de vertrouwde handen van wethouder René Jansen. Dus bij deze de oproep aan alle Dongenaren: laat je van je meest gastvrije en feestelijke kant zien en verwelkom de Roparunners met een oranje lint van 6 kilometer lang.
DUS BIJ DEZE DE OPROEP AAN ALLE DONGENAREN: laat je van je gastvrije en feestelijke kant zien en verwelkom de Roparunners met een oranje lint van 6 kilometer lang!
Kanaalstraat 96a, 5104 AD Dongen
Ik ben Claudia Hooijmaaijers, interieurstylist en samen met Jan trotse eigenaresse van Gordijncentrum in Dongen. Mijn visie is dat je interieur een weerspiegeling van je karakter moet zijn. Laat mij je foto’s en/of

28 mei Doorkomst Roparun



Dat beleef je bij BART!!





Terras open 15.00 - 00.00 uur









open Roparun special: Halve Zolenbier








T. 0162-312284 www.vanpeer.nl BART Tramstraat 27 Dongen

GM VLOEREN DESIGN
Uw adviseur: Rob van Riel

WIJ HEBBEN VOOR U DE MOOISTE KWALITEIT VLOEREN ONDER ÉÉN DAK VOOR ELKE RUIMTE EN IEDERS BUDGET!
parketvloeren | multiplank vloeren | duoplank vloeren laminaatvloeren | click pvc vloeren | natuursteen vloeren tegelvloeren | traprenovatie | vloerverwarming | terrassen | enz.







EEN AVONTUUR VOOR HET LEVEN
Het traject van de Roparun loopt normaliter van Parijs naar Rotterdam. Heel speciaal dit jaar is dat de hele route door Nederland loopt. Geen drie landenloop, wel 530 km non-stop lopen en fietsen van Vliegveld Twente naar de Coolsingel in Rotterdam. Op 28 mei komt de Roparun dit jaar weer dwars door Brabant en zelfs door Dongen!

DOORKOMSTPLAATS DONGEN
Eén van de redenen dat de Roparun ook dit jaar helemaal door Nederland loopt zijn de feestelijke doorkomsten die Nederland vorig jaar voor de teams had voorgeschoteld. Dat betekent dus dat ook dit jaar de lange karavaan van de Roparun Dongen weer aan zal doen. De prijs die Dongen vorig jaar in de wacht sleepte spoort iedereen aan ook dit jaar om Dongen op de Roparunkaart te zetten. Roparunteam ‘t Halve Zolenlijntje hoopt op de medewerking van het gemeentebestuur, AV Atledo en op de steun en het enthousiasme van de Dongense bewoners en ondernemers.

€ 90.000.000,-
Een non-stop estafetteloop van een dergelijke afstand spreekt tot de verbeelding. Maar het gaat niet alleen om de sportieve uitdaging. Stichting Roparun gebruikt het geld dat door
217 teams met deze loop wordt ingezameld om kwaliteit van leven te kunnen geven aan mensen met kanker. Het motto waar iedereen voor gaat is: “Leven toevoegen aan de dagen, waar vaak geen dagen meer kunnen worden toegevoegd aan het leven”. De grootste estafetteloop ter wereld wordt in het pinksterweekend voor de 32e keer georganiseerd. In al die jaren is er al ruim €90.000.000,- voor de palliatieve zorg voor kankerpatiënten bij elkaar gelopen. Een mooi deel van dit gigantische bedrag is bijgedragen door het lokale Roparunteam ’t Halve Zolenlijntje. De meeste van de 26 teamleden wonen in Dongen. ‘t Halve Zolenlijntje staat komend Pinksterweekend voor de 15e keer aan de start voor dit prachtige positieve evenement. De Roparun is een avontuur, is emotie en beleving. Sport, teamwork, het goede doel, alles dit weekend samen.


Roparun doorkomst Dongen: dwars
Op zondag 28 mei komt de Roparun door het prachtige Dongen. Naast de diverse terrassen van de Dongense horeca vormt de feesttent bij Atledo hét het hart van de festiviteiten en biedt een geweldige sfeer voor iedereen die betrokken is bij dit nobele doel. De aanwezigheid van enkele fantastische artiesten, zoals Het Feestkanon, Coverup, De Vrijtetijdrekkers, de getalenteerde Dongense Simone van de Velden en Feestband BAM!, zullen deze dag onvergetelijk maken voor de deelnemers, supporters en Dongenaren. De toegang tot dit feest is gratis en de tent is vanaf 16:00 uur geopend. We starten met heerlijke muziek van onze DJ, waarna diverse Dongense muzikale acts geheel belangeloos hun medewerking verlenen aan het spetterende Doorkomstfeest bij Atledo.

ROPARUN

Samen rennen voor het goede doel. De Roparun is een estafetteloop van meer dan 500 kilometer van Parijs en Hamburg naar Rotterdam, waarbij teams geld inzamelen voor mensen met kanker. Vorig jaar vond de Roparun geheel plaats in Nederland vanwege de nasleep
van corona en ook dit jaar wordt hier nog een keer voor gekozen.
De doorkomst in Dongen in 2022 was al bijzonder groots, waarbij de teams werden aangemoedigd en toegejuicht. En dit jaar gaan we proberen dat te overtreffen.
HET FEESTKANON COVERUP!

Een explosieve ervaring Het Feestkanon, bekend om hun enthousiasme en interactie met het publiek, brengt het feest op gang. Met hun opzwepende feestmuziek zorgen ze voor een onvergetelijke ervaring. De tent zal uit zijn voegen barsten van enthousiasme terwijl Het Feestkanon iedereen meeneemt op een feestelijke muzikale reis.
Eindsestraat 108
Dongen T. 013-5159518
Wilhelminastraat 74 C

5104 GD Dongen 0162-224632

www.cafetarialef.nl
Hits van toen en nu Coverup, één van de meest geliefde coverbands in de regio, betreedt het podium en neemt het publiek mee op een nostalgische tijdreis. Met hun meeslepende optreden en repertoire vol hits van toen en nu, krijgt de feesttent waarschijnlijk geen genoeg van het dansen en meezingen. Coverup brengt een unieke mix van muziekstijlen en zorgt ervoor dat jong en oud zich zullen vermaken.

dwars door de Feesttent bij Atledo

SIMONE VAN DER VELDEN
Dé getalenteerde zangeres uit Dongen. Met haar krachtige stem en charisma betovert ze het publiek keer op keer. Haar optreden in de feesttent bij Atledo was vorig jaar al een ware sensatie en ook dit jaar zal ze met haar muzikaliteit en persoonlijkheid weer iedereen weten te bekoren.
DE VRIJTETIJDREKKERS
- Muzikaal vermaak voor iedereen. De Vrijtetijdrekkers, een band met een uitgesproken naam, brengt een gevarieerd repertoire van meezingers en feestnummers. Ze slagen er steevast in om het publiek te betrekken bij hun optreden en creëren een sfeer van gemeenschap en vrolijkheid.
FEESTBAND BAM!

PROGRAMMA:
16:00 uur: DJ
18:00 uur: Het Feestkanon
18:30 uur: DJ
19:00 uur: Coverup

De energieke feestband Bam! staat garant voor een knallend optreden. Zij zullen maar liefst twee sets spelen. Met hun aanstekelijke muziek en enthousiasme weten ze meteen de stemming erin te brengen. Onder luid applaus zal de feesttent zich vullen met dansende mensen en positieve energie en dát is precies wat al die Roparunners goed kunnen gebruiken!

Onafhankelijk en persoonlijk energieadvies Energiebesparing Verduurzaming www.energiecoachrob.nl

De Slof 3 Dongen
Tel. 0162-313854
20:00 uur: Simone van der Velden

20:30 uur: De Vrijetijdrekkers
21:00 uur: Bam!
22:00 uur: DJ
22:30 uur: Bam!
Kanaaldijk Noord 9 5104BE DONGEN
Telefoon: 0645019320
E-mail: vanloonautomotive@outlook.com


Gerardus Majellastraat 27 5101 BE Dongen Tel. 0162-314727





















De Post & de Nijverheid, gelegen aan de Hoge Ham, een unieke ontwikkeling van 20 appartementen en een commerciële ruimte in hartje Dongen, midden in het leven, vriendelijk, duurzaam en tijdloos. Ontworpen om alles uit het leven te halen.
Wonen en leven in hartje centrum

• 12 heerlijke koopappartementen variërend van 106 m² tot 125 m² op de 1e, 2e of 3e verdieping




• 2 penthouses op de bovenste verdieping van circa 161 m²
• 6 ruime huurappartementen vanaf circa 117 m² op de 1e en vanaf circa 114 m² op de 2e verdieping

• Commerciële ruimte van circa 450 m²



0162 32 16 16 | m@kelaar.com










Dongense St. Laurentiuskerk deelnemer aan de Landelijke Openkerkendag
Tweede Pinksterdag is ook dit jaar weer uitgeroepen als Landelijke Open Kerkendag. Zoals de naam al laat vermoeden zijn dan in het hele land vele kerken geopend met de bedoeling deze van binnen te bewonderen. Want helaas zijn nog steeds veel kerken als er geen diensten zijn gesloten. En een kerk is heel fraai van buiten maar vaak veel mooier van binnen. Bovendien zijn kerken gevuld met allerlei andere kunstzinnige gebruiksvoorwerpen, van kruiswegstaties tot pijporgels en van koperen luchters tot heiligenbeelden.
Uiteraard is de Dongense Laurentiuskerk, als Rijksmonument, dit jaar ook van de partij. Vanaf 10.00 uur in de ochtend tot 16.00 uur in de middag is de kerk geopend. Bezoekers kunnen uiteraard het interieur bezichtigen, de schilderingen van Joan Colette, maar ook het historische Rütter-orgel (1882) bezoeken (om 13.00 uur en 15.00 uur) en, als men dat wil, ook bespelen. Er staan mensen klaar om uitleg te geven of een rondleiding te verzorgen (om 12.00 uur en 14.00 uur) en er is koffie, thee


en limonade verkrijgbaar à €1,-. Veel ‘vreemdelingen’ die de Dongense Koepelkerk bezoeken verbazen zich over de geweldige ruimtewerking van de kerk bij een eerste aanblik.
Architect Jos Cuypers wist inderdaad wel wat hij deed en de ruimte zou nóg indrukwekkender zijn geweest als het schip ook nog was gebouwd, om maar niet te spreken van de 70 meter hoge toren. Dat is er helaas nooit van gekomen en de meeste Donge-
naren fietsen, lopen of rijden vaak achteloos aan het monument voorbij. Maar aanstaande maandag is er dus gelegenheid om dat eens recht te zetten. Dan kan de
‘WIJ GAAN HIER NOOIT MEER WEG!’
Tonny en Joop Weterings wonen al hun hele leven in de Torenstraat
jes’ uit de straat, drinken ze koffie, om de vier of vijf maanden. “De ‘boomers’, noemen wij onszelf. Dan drinken we een bakske en een borreltje. Soms wordt het erg laat op zo’n dag.” Ze vinden het beiden jammer dat er geen straatfeesten meer georganiseerd worden. “Wij hebben een aantal feesten gehad, met een tent op straat. Een tijdje was er niets en toen heeft de jeugd een feest georganiseerd. Daar kwam bijna niemand op af. Dat is wel jammer.”
Hechte familie
bezoeker zich eens uitgebreid verdiepen in Dongens grootste en monumentaalste monument! Wist u overigens, dat er drie van dit soort kerken door Jos Cuypers
zijn ontworpen en gebouwd? Éen staat er in Beverwijk, één in Bussum en inderdaad de mooiste staat in Dongen, zomaar midden in het dorp! Tijd om dát eens van
nabij te gaan bekijken… Maandag 29 mei, Tweede Pinksterdag, tussen 10.30 uur en 16.00 uur. Van harte welkom!
MO20 kopieert uitwedstrijd thuis in hun voordeel
De dametjes van MO20 kunnen verrassend uit de hoek komen. Na de nodige verloren wedstrijden lieten de GroenWitte ladies al eens zien dat ze hun mannetje konden staan en versloegen de nummer 3 op de ranglijst. Vandaag bewezen ze zichzelf weer in de wedstrijd tegen vv Oosterhout. Deze kampioenskandidaat (de nummer 2 op de ranglijst) had vandaag een hele kluif aan de voetbalsters uit Dongen (de nummer 6 op de ranglijst).
Geen zin in herhaling
Tonny en Joop wonen hun hele leven in de Torenstraat.
Tonny (72) en Joop Weterings (77) wonen allebei (bijna) hun hele leven in de Torenstraat. Tonny werd er geboren, Joop werd geboren in Leiden, maar verhuisde toen hij drie jaar was weer terug naar Dongen. Het verhaal over een bijzondere straat.

DOOR LIA VAN GOOL
‘Zeedijk’
“Mijn vader en moeder woonden op Torenstraat 7,” vertelt Joop Weterings. “In de oorlog zijn zij naar Leiden verhuisd, waar mijn vader schoenmaker werd. Toen ik drie jaar was, kwamen wij weer in Dongen wonen.” Tonny vertelt dat ook haar moeder en tante in de Torenstraat hebben gewoond. “Het was een hele gezellige straat. Vroeger noemden ze het hier ook wel ‘de Zeedijk’. Dat kwam omdat er tafels en stoelen op straat werden gezet.” Op de stoepjes voor de huizen, op straat, werd regelmatig ‘een bakske’ gedronken.
Elitekant
Lachend vertellen Tonny en Joop dat er vroeger in de Torenstraat een ‘elite kant en een ’arme’ kant was. “De even kant, dat was de elite. Die hoorden bij de ‘Hamse Kerk’. De oneven kant was de arme kant, die bij de Jozefkerk hoorden.” Tonny was van de elite. Zij trouwde met ‘eentje van de arme kant’. Tonny woonde op nummer 20 en nummer 34, voordat zij trouwde met Joop, die op nummer 7 woonde. “Toen wij trouwden, zijn wij op nummer 18 gaan wonen. Wij hebben niet ver gezocht naar een partner.”
Charme
De charme van de straat ligt vooral in vroegere tijden, vinden Tonny en Joop. “Toen was het een mooie straat, met veel bomen.
Wij waren allemaal één, wij buurten met elkaar, er waren feestjes en op dit stukje straat werd altijd gespeeld.” De bomen stonden in het midden van de straat. “Dat was mooi. En toen wij trouwden waren er ook nog niet zoveel auto’s.”
Tonny is nog steeds bevriend met twee vriendinnen van vroeger. “Wij hebben het hier, in de gang naast het huis, regelmatig heel gezellig gehad. Met de Ronde van Dongen zetten wij tafels neer. Wij dronken een pilske en een wijntje. We hebben altijd leut gehad in de straat.” Joop vertelt dat Drumbrand Beatrix in de Torenstraat is ontstaan. “Er waren altijd kinderen die muziek maakten met trommels van blik.”
Clubje
De broer van Joop, Tom, woont niet meer in Dongen. Hij was vroeger lid van een clubje dat ‘Tia’ heette. Tom vertelt, via de telefoon: “Dat waren allemaal jongens uit de straat, van de slechtste kant van de Torenstraat.” Op de vraag of hij nog weet wat ze toen allemaal uithaalden, blijft Tom het antwoord schuldig!
‘Boomers’ Er is veel veranderd in de straat, de laatste jaren, vinden Tonny en Joop. “Vooral aan de overkant ius veel jeugd komen wonen. Zij zeggen wel ‘hallo’ en ‘goedendag’. Eén vrouw, die hier ook al langer woont, komt nog wel eens ‘een bakske’ drinken.” En, met ‘de oud-
Tonny en Joop hebben één zoon, Jurgen. Jurgen is getrouwd met Marjolein en heeft twee kinderen, Maaike van 20 en Bart van 18. “De kinderen en kleinkinderen komen wel drie keer in de week hier naar toe. Wij zijn een hechte familie.”
Joop vertelt dat de familie Weterings ook een hechte familie is. “Wij hadden een eigen carnavalsvereniging, ‘Ons Grut’. Die vereniging is overgenomen door de jeugd van de ‘Weteringsen’.”
Camper
Tot voor kort gingen de twee regelmatig op pad met de camper. Die hebben ze een paar maanden geleden verkocht, omdat Tonny niet mee kan fietsen. “Je hebt wel een fiets nodig op een camping, anders zit je een hele dag voor de camper.” Ze vinden het wel jammer, maar het is niet anders. “Nu heb ik een elektrisch brommertje,” zegt Tonny. “En dat gaat prima.”
Nooit meer weg
“Wij gaan hier nooit meer weg,” zeggen Joop en Tonny. “Wij hebben niet zo’n grote ‘werft’ hier en het huis is fijn. Wij gaan niet uit Dongen weg en onze kinderen ook niet.” Tonny vult aan: “Ik kan mijn kleinkinderen niet missen.” Het is duidelijk. Tonny en Joop hebben altijd ‘gère’ in de Torenstraat gewoond. “En wij wonen er nog graag. Onze kleinzoon Bart zegt altijd: ‘Als jullie uit de tijd zijn, koop ik jullie huis’,” besluiten ze lachend.
Oproep!
Woont u ook al uw hele leven in dezelfde straat en wilt u daarover vertellen? Laat het me weten. Stuur een berichtje naar liavangool2909@gmail.com of bel 0653245070.
Van meet af aan was het duidelijk dat de thuisploeg geen zin had in een herhaling van de uitwedstrijd. Volle vaart werd richting gastgoal gestoomd en de eerste 10 minuten werd het spel op de verre helft gespeeld. Een enkele keer kwam de bal over de middenlijn maar werd dan vakkundig door de verdediging onderschept en linea recta retour gezonden naar de andere kant van de lijn. De wedstrijd is een kwartier onderweg wanneer een DVVC-ster de bal na een mooie aanname in sneltreinvaart van de Oosterhoutspeelster verwijderd, de bal op haar slof neemt en één op één bij de keepster een mooi hoekje opzoekt om de bal tegen het net te knallen. 1-0 Dat is alvast een opsteker.
De Oosterhoutse dames laten zich niet onbetuigd en na de aftrap rolt de bal vervaarlijk dicht bij de thuisgoal. Met vereende krachten wordt de goal leeg gehouden en zijn aanvallers weer teruggedrongen in de verdedigingsrol, want de voormalige verdedigsters stomen weer op naar de andere helft van het veld. Het spel golft zo wat heen en weer en

DVVC probeert druk te blijven zetten. Dat lukt aardig want het spel is zelden zeer gevaarlijk voor de thuisploeg al is er op de lauweren rusten zeker niet bij. Na nog weer dik een kwartier doet zich wederom een mooi kans voor om de score op te krikken. En dat gebeurd dan ook. Voor de tweede maal is de thuisploeg trefzeker. 2-0. In de resterende tijd krijgen ze nog wat kleine kansjes waarvan ze er één benutten. Wanneer het tijd is voor de thee hebben de GroenWitte een mooie voorsprong van 3 treffers en 0 tegendoelpunten.
Vasthouden?
Vraag is of de dames deze voorsprong kunnen vasthouden en niet al reeds al hun kruit hebben verschoten. Voor de fans langs de lijn zijn de eerste minuten in de tweede helft niet bijster geruststellend. Het spel lijkt gekeerd en speelt zich te veel, te lang, te dicht bij de thuisgoal af. Die middenlijn lijkt heel ver weg. Het lijkt een bétje ingekakt, een beetje bevreesd. Na een paar benauwde minuten komt echter de schwung en de felheid weer in het spel. Balbezit betekent, zeker op ‘vijandige’ helft, kansen kunnen creëren
voor jezelf en de boot afhouden voor de ander. Immers het inmiddels gevleugelde gezegde:
“Als wij de bal hebben, kunnen zij niet scoren”, staat nog altijd als een huis. Doelpogingen van het thuisteam zijn er zeker, vooralsnog leiden ze echter niet tot een hoger doelsaldo. Alle disciplines werken eendrachtig samen, de ware teamgeest van een teamsport waardig. Dat voorkomt ook dat er gevaarlijke, langdurige uitbraken van de gasten kunnen plaatsvinden en daarmee ook dat de thuisploeg een tegengoal moet incasseren.
Wanneer het fluitsignaal klinkt is er een kopie-uitslag-in-spiegelbeeld van de uitwedstrijd. Daar tekende vv Oosterhout 3 punten op met 3 goals, vandaag is het DVVC dat Oosterhout puntloos naar huis stuurt door 3x te scoren en zelf een clean sheet te houden. Gefeliciteerd dametjes.
KNVB Final League MO20-teams
De speelsters nodigen iedereen uit op 10 juni aanstaande bij DVVC. Op het Sportpark Dongekant wordt dan de KNVB MO20 Final League gespeeld met zes teams in twee Poules. Aanvang van de eerste wedstrijden is om 12.00uur. Kom dit team aanmoedigen, kom genieten van een leuke, gezellige voetbalmiddag.
Een perfecte middag om (hernieuwd) kennis te maken meisjes/dames-voetbal. Tot dan, tot 10 juni.
Doek valt voor Dongen in 3e divisie
Met nog één uitwedstrijd te gaan, moet Dongen na een verblijf van zeven jaren in de 3e Divisie, het volgende seizoen een trapje lager gaan spelen. Drie wedstrijden geleden had het elftal van Osman Erbas alles nog in eigen hand. Het liep allemaal anders. De meest belangrijke wedstrijd van het seizoen, thuis tegen Baronie, liet de ploeg het afweten. Toen volgende de inhaalwedstrijd doordeweeks tegen UNA in Veldhoven. Een wederopstanding? Door het niet afronden van de vele mogelijkheden werd het een gelijkspel. En dan de laatste thuiswedstrijd tegen Groene Ster. Een ploeg die op twee fronten streed: nacompetitie ontlopen en/of periodetitel pakken?
Door Piet Scheepers
Snel vergeten die wedstrijd tegen Baronie thuis!
Dat was unaniem de opmerking van de vaste aanhang van Dongen. Diverse uitlatingen werden de wereld in gegooid. Niet voor herhaling vatbaar. Een ding is zeker: Baronie trad Dongen tegemoet alsof hun leven ervan afhing. Dat was dan ook zo. Dongen liet zich als een mak schaap naar de slachtbank leiden. Daar waar de geel/blauwen met het mes tussen de tanden de Bredase buurman te lijf hadden moeten gaan, stelde de thuisploeg danig teleur! Het werd dan ook een schamele 1-2 nederlaag. Dongen
DE GROOTSTE COLLECTIE BANKSTELLEN
DRAAI FAUTEUIL MAREINA IN DIVERSE STOFFEN, MICROLEDER & ECHT LEDER














was weer afhankelijk van Baronie. Het moest dan zelf alles winnen en Baronie moest steken laten vallen.
Inhalen bij UNA
Op de doordeweekse dag, daags voor Hemelvaartsdag, stond de inhaalwedstrijd op het programma. De voorbesprekingen waren duidelijk. Dongen moest de slag op het middenveld winnen! Dan was er iets te halen. UNA had juist een fikse nederlaag opgelopen tegen Groene Ster. “Wij moeten het UNA moeilijk maken,” was het credo. Vanwege verplichtingen elders was UNA op vier plaatsen gewijzigd. Dongen begon wat slordig aan de wedstrijd. Het inspelen van de bal was niet zuiver waardoor UNA kon
opbouwen. Doordat Dongen hoog druk zette kon dit wel eens verkeerd aflopen. Zo ook in de 20e minuut. Pieter Jan Scheerlinck miste de bal waardoor UNA de mogelijkheid kreeg om de openingstreffer te scoren. Daarbij bleef het gelukkig voor Dongen dat vanaf dat moment weer het heft in handen nam. Theo Martens vuurde kort na elkaar enkele schoten op het UNA-doel af. Het resultaat was een pegel op de lat. Invaller-doelman Giel Flokstra had hierop geen antwoord. Hij zou in de wedstrijd uitgroeien als de grote sta in de weg voor Dongen. Maar ook Manof-the-Match. Kort na rust werd Rijk Siemerink binnen de zestien van achteren aangetikt. Scheidsrechter Jeremy Lensink kon niets anders geven dan een strafschop. Fatih Kamaci rondde deze loepzuiver af. Hij had nog geen kwartier later de 0-2 op zijn schoen toen hij slordig balspel in de UNA-verdediging onderschepte. Alleen voor doelman Flokstra schoot hij de bal in de lange hoek. In een reflex stompte de doelman de bal corner. Op de vraag of Kamaci, oftewel Dongen in goeden doen, deze kans wel zou benutten reageerde Kamaci: “De keeper hield deze bal
er prima uit!” Hierna kreeg Dongen volop kansen om de magere voorsprong te vergroten. Het zou anders aflopen. Max van Akker kopte de gelijkmaker binnen. UNA had tot dat moment geen goede kans gehad! Het slotoffensief om alsnog drie punten te pakken werd een hardloopwedstrijd van beide teams die hoog druk zetten. Via uitvallen probeerden beiden de winst te pakken. Giovanni Bombarda was heel dichtbij een doelpunt. Hij zag zijn inzet op de lat afketsen. Grote winnaar? Baronie. Het zag Dongen niet dichterbij komen. Met nog twee wedstrijden te gaan hing Dongen aan een zijden draadje!
Dongen - Groene Ster
Daar waar de KNVB de voorlaatste zondag alle wedstrijden gelijktijdig wilde laten beginnen, gooide Groene Ster roet in het eten. Eerste een klapband met de bus en daarna in een file rond Eindhoven. Uiteindelijk begon de wedstrijd een uur later dan gepland. Ondertussen was ook Baronie thuis begonnen aan de klus tegen Unitas. Bij Dongen was al bekend dat de Bredaase ploeg voorstond. Geen
BOXSPRINGS VAN TOP KWALITEIT
AL VERKRIJGBAAR VANAF 100 CM IN MASSIEF EIKEN IN DIVERSE VORMEN, KLEUREN & AFWERKINGEN
SALONTAFEL SET HUGO




EETTAFELS VOLLEDIG OP MAAT VANAF €399,-









ONDERHOUDSVRIJ !
2 x ELEKTRISCHE LATTENBODEMS & 2 x POCKETVERING MATRAS

VOOR: € 1095,- VAN: €1595,DIVERSE DEELBARE LEDIKANTEN
goed teken dus voor Dongen. Dongen kroop in de 12e minuut door het oog van de naald toen een schot op doel van linkerspits Shaquille Simmons op de paal terug het veld in spatte. De Limburgers waren traag in de opbouw waardoor Dongen zijn manschappen verdedigend kon wegzetten. Het spel bleef op en neer gaan waarbij Wessel Sprangers op sommige hachelijke momenten zijn doel schoon hield. Dongen kwam in de 38e minuut op voorsprong door een doelpunt van Fatih Kamaci die een snel uitgevoerde aanval prima afrondde. De vele meegereisde Limburgers hoopten tijdens spelhervattingen op hun schutter, rechtsback Dylan Zwartjes. Door goed opstellen van de Dongenmuur, wist hij geen bres te slaan. Dongen kreeg na rust goede kansen om de voorsprong te vergroten. Kamaci, alleen voor de doelman op de achterlijn, passeerde de doelman maar zag zijn inzet via de paal voorlangs gaan. Sel Bastmeijer kopte een inzet in de handen van de doelman. Giovanni Bombarda kopte op de lat en kreeg hierna nog een goede kopkans, maar ook deze viel niet in het netje. Het werd steeds stiller op het sportpark. Het publiek had inmiddels vernomen dat Baronie een ruime voorsprong had genomen. Bij winst van Dongen was de laatste wedstrijd nog iets mogelijk. Het pakte anders uit. Met nog ruim twintig minuten op de klok mocht Groene Ster een vrije trap nemen. Weer was het Zwartjes die deze voor zijn rekening nam. Hij krulde bal richting de vijf meter. In een kluwen van spelers was het Dennis Petit die de bal achter doelman Sprangers tikte. Een gelijkspel was als een verloren wedstrijd; dus alles op de aanval. Helaas alsof het zo moest zijn. Juist de twee verdedigers die aan het einde van het seizoen afscheid nemen bij Dongen, speelden de hoofdrol in de winnende treffer voor de gasten. Een eigen doelpunt van Pieter Jan Scheerlinck bezorgde de gasten de 1-2 zege. “Misschien wel tekenend voor het seizoen om op deze wijze te verliezen,” werd langs de lijn berustend opgemerkt. “De laatste druppel uit de gifbeker was vandaag opgemaakt!” Volgende week naar Unitas en daarna uithuilen en opnieuw beginnen.
COLLECTIE
Olympia verliest slotduel competitie
Afgelopen zaterdag mocht Olympia-1 aantreden voor de laatste wedstrijd van dit seizoen tegen SSW uit Dordrecht. De thuiswedstrijd had een minder fijn verloop gehad en daardoor was de belangstelling van de supporters om deze uitwedstrijd te bezoeken stukken minder dan bij alle ander uitwedstrijden dit seizoen. Normaal zijn er toch wel een 30-35 supporters die al het hele jaar de moeite nemen om onze jongens te komen aanmoedigen, maar deze wedstrijd waren er maar acht supporters op het terrein van SSW te bekennen. Bij aankomst toch even de kantine in en we werden daar zeer welkom ontvangen door de Dordtse volksclub. De wedstrijd stond onder leiding van een 20-jarige scheidsrechter, maar deze had de touwtjes gelijk stevig in handen.
In de vierde klasse zijn we dit seizoen dus scheidsrechters van 20 tot 83 jaar tegengekomen.
Na een kleine 20 minuten spelen was de eerste echte kans voor Olympia, maar Ayhan wist deze niet te verzilveren. In de 25e minuut een goal van SSW maar deze werd terecht afgekeurd nadat de scheidsrechter met onze grensrechter had gesproken. De onsportieve reacties van SSW deed ons weer aan de thuiswedstrijd denken en de toon was gezet. In de 36e minuut een prachtige goal van Nick, maar ook deze werd niet goedgekeurd.
Sam lag op de grond en gaf aan niet verder te kunnen en viel uit met een hamstringblessure en zijn vervanger was Thieu. In de 39e minuut scoorde SSW de 1-0 waarbij enkele SSW spelers opnieuw onsportief gedrag vertoonde.
De volgende uitvaller
Enkele minuten later de volgende uitvaller bij Olympia. Nick kon niet meer verder vanwege een blessure aan de onderrug en dat betekende dat Bas v/d Kemp
DA Ingrid Liberty dames 1 wint kraker en verovert koppositie

na 5 jaar afwezigheid weer eens mocht meedoen met het eerste ( volgens Bas zelf was het 20 kilo geleden, en heeft hij de medaille van het toen behaalde kampioenschap nog steeds). Nadat de sterk leidende scheidsrechter had gefloten voor het rustsignaal weer even de gezellige kantine bezocht met alle acht Olympia-supporters. Wat er in de rust tegen de scheidsrechter is gezegd, blijft een raadsel maar deze was geen schim van de sterke scheids uit de 1e helft. De 2-0 viel na een kleine drie minuten voetbal in de tweede helft. SSW kreeg een vrije trap vanaf 9 meter van de Olympia achterlijn welke in eerste instantie door Jim werd gevangen, maar nadat deze uit zijn handen viel, helaas net over de doellijn rolde. De aansluitingstreffer
Olympia rechtte de schouders en ging opzoek naar de aansluitingstreffer. Deze viel al in de 51e minuut maar deze werd zeer onterecht afgekeurd.
Even later mocht Sven een vrije trap vanaf 5 meter voor de middenlijn nemen en legde deze keer de bal wel panklaar zodat Espen met een prachtige goal de 2-1 kon aantekenen. In de 75e minuut mocht de debutant van vorige week, Wesley Lok, nog invallen voor de moegestreden Thymo de Bruijn. SSW scoorde vervolgens de 3-1, welke gemaakt werd door een speler die buitenspel stond. Dus het vele opvallende tijdrekken en geklaag tegen de leidsman had dan toch zijn vruchten afgeworpen. Met nog een paar minuten spelen viel de 3-2 nadat Jim de bal na een snelle uittrap bij Espen wist de bezorgen en deze na eenmaal gestuiterd te hebben weer netjes inschoot. Helaas een wedstrijd die verloren werd waarbij een gelijkspel meer dan terecht zou zijn geweest. Echter werd de vorige wedstrijd onterecht gewonnen dus dat stond dan weer gelijk.
Afgelopen zondag 21 mei stond er een hele belangrijke wedstrijd op de agenda thuis tegen Pijnacker dames 1. Dit team is de directe concurrent van DA Ingrid Liberty dames 1 voor de koppositie in de poule en staan op dit moment op de eerste plek omdat zij een hoger doelsaldo hebben. De zenuwen zaten er goed in bij Liberty want de dames wisten dat ze door het gaatje moesten gaan om de drie punten in Dongen te houden.
Pijnacker begon het eerste kwart fel met een hoge druk aan de wedstrijd. Na zo’n vijf minuten speeltijd was de spanning er wat af bij de dames van Liberty en kwamen zij wat beter in de wedstrijd. Er werden een aantal mooie aanvallen gecreëerd door zowel Liberty als Pijnacker, maar de scherpte voor het openingsdoelpunt ontbrak nog. Tegen het einde van het tweede kwart was het DA Ingrid Liberty dames 1 die het eerste doelpunt van de wedstrijd op het scorebord zette. Na wat gerommel in de cirkel van Pijnacker kwam de bal bij Chelsea van Helmond in de stick. Ze raakte de bal niet helemaal goed waardoor deze via een stick van de verdediging van Pijnacker in het doel belandde. Daarmee ging DA Ingrid Liberty dames 1 met een 1-0 voorsprong de rust in. De dames werden door coach Pieter van ’t Hart positief toegesproken en er werd benadrukt dat Liberty fel uit de rust moest komen. Normaliter heeft DA Ingrid Liberty dames 1 wat moeite met het derde kwart, maar nu was de focus gelijk herpakt. Over en weer werden er wat strafcorners gehaald door beide teams die niet benut werden, maar de bovenhand was duidelijk voor de dames van Liberty. Halverwege het derde kwart nam Daphne Pijnenburg de bal knap mee langs de achterlijn in de cirkel van Pijnacker en be-
diende ze de vrijstaande Chelsea van Helmond bij de tweede paal: doelpunt voor Liberty! DA Ingrid Liberty dames 1 ging maar door dit derde kwart, en zo speelde Silke Verbunt een prachtige bal richting Femke Kuppens die op dezelfde manier langs de achterlijn opkwam en ditmaal was het Daphne Pijnenburg die vrijstond bij de tweede paal en de bal in het doel tikte. Twee snel achter elkaar opgezette en prachtige aanvallen, en een verdiende 3-0 voorsprong. De dames van Pijnacker bleven vechten het vierde kwart. Keepster Emma-Lynn van Mierlo moest een aantal keer in actie komen en bracht op knappe wijze redding voor Liberty. De druk van Pijnacker op de verdediging van Liberty was hoog en zo scoorde ze ook een tegendoelpunt: 3-1. Direct daarna werd er in de cirkel van Pijnacker een flinke overtreding gemaakt van de keepster op Femke Kuppens. Er werd een
strafbal gegeven en Chelsea van Helmond nam plaats achter de bal. Ze hield haar hoofd koel en benutte deze kans feilloos. Hiermee stond DA Ingrid Liberty dames 1 op een zeer comfortabele 4-1 voorsprong. Pijnacker bleef de slotfase vechten waardoor ze nog een aantal strafcorners toegewezen kregen. Ze wisten er
een te benutten en de eindstand werd daarmee bepaald op 4-2 voor Liberty.
DA Ingrid Liberty dames 1 wint deze absolute kraker en verovert de koppositie in de competitie. De eerstvolgende wedstrijd is op zondag 4 juni en wordt gespeeld tegen Bleiswijk dames 1.
Den Hamse Bok Liberty Heren 1 wint thuis van Boxmeer
Een belangrijke wedstrijd voor de mannen uit Dongen tegen de rode lantaarn van de competitie Boxmeer. Een overwinning zou de degradatiestrijd nagenoeg beslissen bij een gunstig resultaat van HOCO tegen Heeze. Vorige week won Liberty de kraker tegen Heeze en voor speelronde 19 is het gat tussen Liberty en Heeze 3 punten. Ook stond er veel op het spel voor Boxmeer want dat streed voor zijn laatste kans om degradatie af te wenden.
Het niveau van de wedstrijd was niet fantastisch. Liberty was technisch de betere ploeg maar Boxmeer stelde zich zeer verdedigend op, hierdoor was het wachten op het eerste doelpunt. Dat eerste doelpunt viel na een paar eerdere kleine mogelijkheden pas in het tweede kwart: ‘Topscoorder Mick van Outhorst mocht aanleggen voor een strafcorner en sloeg in 2 instanties de bal hard tegen de plank.’ Boxmeer moest nu meer gaan aanzetten maar leek niet bij machte dus veranderde het spelbeeld amper. Liberty wachtte geduldig
ONI maakt het zichzelf onnodig lastig
Na de mooie overwinning op Desk vorige week had ONI nu opnieuw een driepunter nodig om zich definitief veilig te spelen. In de wedstrijd tegen Haaften leek men lang op de goede weg maar moest het in de slotfase toch nog de gelijkmaker incasseren.
Op voorhand was duidelijk hoe de zaken er voorstonden. Om niet in allerlei rekenwerk terecht te komen moest er gewoon gewonnen worden. Voor Haaften telde hetzelfde. Alleen via een overwinning behielden zij de kans om de nacompetitie te ontlopen.
Het begin van de wedstrijd was vrij rommelig. Al vrij snel werd duidelijk dat ONI wel de iets beter voetballende ploeg was maar dat het lastig werd om gevaar voor het doel te stichten. Haaften hanteerde veelal de lange bal maar was hiermee ongevaarlijk. Voetballen was sowieso lastig op het slechtste veld van deze competitie, dit dus vooral in het nadeel van ONI. De rust werd bereikt met een 0-0 stand en dus moest ONI op zoek naar meer in de tweede helft. Dit kwam er gelukkig ook via een mooie aanval. De goed spelende Floris Wouters stuurde spits Marc Ravensbergen met een mooie pass de diepte in. In de 16 kapte deze vervolgens tweemaal zijn man uit en schoof de bal langs de keeper. Een verdiende voorsprong en eigenlijk de wedstrijd in handen. Haaften bleef proberen met de lange bal maar deze werden makkelijk onschadelijk gemaakt. Helaas 5 minuten voor tijd werd een situatie door een verdediger van ONI niet goed ingeschat. Hij raakte een aanvaller van Haaften in het puntje van de 16 en deze ging neer. Een penalty tot gevolg en deze werd vervolgens beheerst binnen geschoten.
Nog 1 punt nodig
In de laatste minuten probeerde beide partijen de winst er nog uit
te slepen maar gescoord werd er niet meer. Dit houdt in dat Haaften samen met MVV nu zeker is van de nacompetitie. Alleen NEO uit Sprang Capelle kan de oranjehemden nog achterhalen. Deze moeten dan winnen en ONI moet voor hun van Dongen verliezen.
Dit ook nog met ruime cijfers want ONI heeft een doelsaldo van +11 ten opzichte van NEO. Dongen komt volgende week op bezoek en moet winnen om winnaar te worden van de Tweede periode.
Hierin gaan zij aan kop met een positief doelsaldo van +3 t.o.v. Sleeuwijk. ONI heeft dus nog 1 punt nodig om zich definitief veilig te stellen. Het gaat dan ook een kraker worden zaterdag op sportpark ’t Wiel. We hopen op mooi weer en veel toeschouwers om beide ploegen aan te moedigen. Na afloop is er uiteraard nog een gezellig samenzijn met BBQ om het seizoen af te sluiten met hopelijk voor beide ploegen het gewenste resultaat.
In verband met de vervroegde deadline vorige week, waren we te laat met het aanleveren van verslag ONI - Desk. Wij willen dit u niet onthouden, hierbij alsnog:
Afgelopen zaterdag behaalde
ONI 1 een klinkende, en een zo belangrijke zege op het jeugdige team van vv Desk 1. ONI heeft nu nog 3 punten nodig met nog 2 wedstrijden te gaan om zichzelf veilig te spelen. De wedstrijd werd aangevangen op een zonovergoten vers gemaaid grasveld onder het toeziend oog van vele toeschouwers onder wie ook spelers van
vv Dongen zaterdag.
Ook oud-voorzitter Koos
Mouthaan was van de partij en zag zo zijn geliefde clubje winnen. Het was al een hele lange tijd geleden dat de grasmat er zo bijlag. Chapeau voor de persoon die dit heeft bewerkstelligd! Was een beetje oude tijden herbeleven. Wat zou Pieter Faro (Mister ONI) hier trots op zijn geweest! Alle omstandigheden waren dus top maar nu moest het op het veld nog gebeuren. De trainer van ONI beschikte nu eens over zijn voltallige selectie. Zelfs de reservebank was zeer sterk gevuld deze middag. Helaas gooien blessures en weekendjes weg nogal eens roet in het eten maar daar was nu geen sprake van. ONI begon geconcentreerd en gedreven aan de wedstrijd. Met een goed voetballend collectief creëerde men kansen. De coaching onderling was positief, wat het spel ten goede kwam. In de 28e minuut was het Lars van der Kleetersteeg die na een perfecte voorzet van Rik Fioole de 1-0 met een kopbal op het scorebord bracht. Net na de 1-0 moest Scotty van Leeuwen het veld met een blessure verlaten maar zijn vervanger Sam de Weijer stond gelijk zijn mannetje met zijn invalbeurt. Hierna werd ook Sander Blom alleen voor de keeper gezet maar die wist zijn inzet nog net onschadelijk te maken. De rust werd ingegaan met een 1-0 voorsprong.
Tweede helft
Na rust was het weer Rik Fioole die nadat hij de bal onderschepte een prachtige assist gaf op zijn broer Niels Fioole en hem de gelegenheid gaf, om de 2-0 op bord te zetten. Zo geschiedde. De kopjes van de spelers bij Desk gingen hangen, maar het iets te laconiek
ingrijpen van de verdediging van ONI gaf Desk de aansluitingstreffer. Een afgeslagen bal werd door een speler van Desk Vol op de wreef genomen en op deze streep was zelfs keeper Hendricx kansloos. De supporters van ONI hielden hun hart vast ”het zou toch niet weer” maar het was Marc Ravensbergen die een bal op eigen helft onderschepte en er razendsnel uitkwam. Hierna rukte hij op tot in het strafschopgebied en gaf daarna de bal perfect op maat aan de ingevallen Tom Kolkert. Tom wist hier wel raad mee en ja daar was de 3-1. De snelle en hardwerkende Marc Ravensbergen was een plaag voor de verdediging van Desk. Overal dook hij op en het was Ravensbergen zelf die de 4-1 maakte. Hij werd achteraf dan ook terecht tot man van de wedstrijd uitgeroepen en werd 10 minuten voor tijd moegestreden gewisseld voor de jeugdspeler Jens van Loon. De 5-1 werd in de blessuretijd gemaakt door de ingevallen Jorg Blom. We mogen niemand niet te kort doen maar wat heeft Sander Blom weer veel vuile meters voor het team gemaakt. Het behaalde resultaat is een geweldige teamprestatie.
Uitslagen 20 mei
Haaften1 - ONI 1 1-1
ONI 2 - De Fendert 2 4-1
ONI 4 - DVVC 2 2-4
Desk JO18 1 - ONI JO18 1 10-0
ONI JO13 1 - FCTilburg JO13 3 4-0
ONI JO11 1 - SCO JO11 3 4-7
Programma 27 mei
14.30 uur: ONI 1 - Dongen 1
Programma 26 mei
De heren ONI 35+1 spelen aanstaande vrijdag hun wedstrijden bij vv Raamsdonk. Aanvang wedstrijden 19.00 uur.
op foutjes in de achterhoede van Boxmeer en nam geen risico in het druk zetten. Dat Liberty niet in grootste vorm verkeerd werd vertaald in lang wachten op het volgende doelpunt. In de tweede helft kwam dat tweede doelpunt na ongeveer 8 minuten spelen: ‘De keeper redde een paar keer vaardig maar werd uiteindelijk geklopt door een harde klap van links midden Gijs Jochems’. Heel even leek Boxmeer voor zijn laatste kans te gaan maar veel verder dan de 23 meter lijn kwamen zij eigenlijk niet. Liberty zijn organisatie stond
goed en Boxmeer leek er niet echt meer in te geloven.
De 3-0 viel uit een mooi aanval waar alle drie de aanvallers bij betrokken waren: ‘Linksvoor Maik Vermeulen omspeelde zijn verdediger en vond Mick Asselman in de cirkel. Mick hield overzicht en speelde Tim Verkijk hoog aan. Die bleef echter rustig en duwde de bal uit de lucht de goal in.’
Het slotakkoord was voor Mick van Outhorst die zijn tweede goal van de dag maakte wederom uit een strafcorner. Een prima 4-0 uitslag voor de ranglijst omdat HOCO van Heeze wist te winnen. Over 2 weken speelt Liberty de uitwedstrijd in Wijchen, een ploeg dat strijd om de promotieplekken. Bij een overwinning is Den Hamse Bok Liberty heren 1 nog een jaar verzekerd van de derde klasse.
Tweede Pinksterdag Fietstocht bij P.V. Dongen
Op 29 mei, 2e Pinksterdag, wordt door de postduivenvereniging Dongen in samenwerking met MFC Langstraat voor de 21e keer weer een prachtige fietstocht georganiseerd langs de mooiste plekjes van de Langstraat tussen Dongen, Loon op Zand, Sprang-Capelle en Waspik. Het vertrekpunt is bij het clublokaal van de postduivenvereniging Dongen, Hertog Janstraat 32. U kunt starten tussen 10.00 uur en 11.00 voor een afstand van ongeveer 40 kilometer. Bij de aangegeven locaties onderweg wordt koffie met een broodje aangeboden. Het inschrijfgeld bedraagt € 6,- per persoon. Kinderen tot 12 jaar mogen gratis deelnemen. De weerstations geven voor 2e Pinksterdag prachtig fietsweer aan. Genoeg redenen om te genieten van een prachtige fietstocht.
Biljartsport
Hanny Kemmeren 40-jaar lid b.v. ’t Vaartje
Tijdens de jaarvergadering van Biljartvereniging ’t Vaartje is Hanny Kemmeren gehuldigd. Hanny is inmiddels meer dan veertig jaar lid van deze vereniging. In 1983 namen Hanny en haar echtgenoot Ton café ’t Vaartje over. Dat was voor haar een prima reden om lid te worden van ’t Vaartje. Ze sloot zich onmiddellijk aan bij het damesteam. Toen was het in Dongen nog niet mogelijk om in gemengde teams te spelen. Jaren later speelde ze ook in gemengde teams. Naast de inzet als biljarter, heeft ze ook als kastelein bijgedragen aan het floreren van de biljartclub. Mooi is dat ze op deze vergadering ook in het bestuur werd gekozen. De vereniging kan dus van haar tomeloze inzet blijven genieten. Voorzitter Embert Broekhoven overhandigde de jubilaris een aandenken en een mooie bos bloemen.

Weekendkamp Olympia’60 daverend succes

Wedstrijden week 21
Vrijdag 26 mei
UIT
19.30: FC Right’Oh VR30+1 - DVVC VR30+1
20.00: DVVC VR30+1 - Raamsdonk VR30+1
20.30: Waspik VR30+1 - DVVC VR30+1
21.00: DVVC VR30+1 - Dongen VR30+1
(worden gespeeld op Sportpark De Biezen)
Zaterdag 27 mei THUIS
09.00: JO14-1JM - DIA JO14-1
Zaterdag 10 juni THUIS (week 23)
MO20 Final League Toernooi Poule A
12.00: DVVC MO20-1 - RFC MO20
12.45: RFC MO20 - Cluzona
13.30: Cluzona - DVVC MO20-1
Poule B
12.00: Beek Vooruit MO20 - Kruiningen MO20
12.45: Kruiningen MO20 - vv Oosterhout MO20
13.30: vv Oosterhout MO20 - Beek Vooruit MO20
14.45: Kruisfinales
THUIS JO10-1
Groepsfoto weekendkamp Olympia’60 2023.
Eigenlijk is dit een titel die niemand verrast. De ervaren kampstaf wist ook dit jaar de ruim 140 kinderen weer een geweldig weekend voor te schotelen. Het programma is al jaren beproefd en is ook dit jaar succesvol losgelaten op de jongen Olympiaantjes.
Een stormbaan, het hilarische
bubblebal, doeltrappen (hard en zuiver) en vele andere leuke spellen werden er gespeeld. Nieuw dit jaar was “leider trappen”; een leid(st)er moest een traject afleggen op een fiets, maar werd intussen vanaf de zijkant belaagd met ballen die door de deelnemers werden geschoten. Of de leiders het er mee eens zijn is niet bekend, maar ook dit spel viel in goede aarde.
Tussen alle activiteiten door werd er natuurlijk gezorgd voor heerlijke maaltijden. Dankzij vele sponsors kon de keukenstaf geweldig lekkere schotels opdienen, voor zover hier nog behoefte aan was na teveel chips en snoep tussendoor…
Op zaterdagavond uiteraard de traditionele playbackshow. De deelnemers hadden zich goed voorbereid en hadden diverse verkleedspullen en accessoires bij zich. Een ervaren Olympia-jury had het erg moeilijk om bij zoveel spektakel winnaars aan te wijzen. Op zondag ging de jongste jeugd mooie hutten bouwen in het bos,
terwijl de ouderen nog een afsluitend toernooi speelden. Dit alles om uiteindelijk bij de prijsuitreiking de grootste trofee te scoren (of waren ze nu allemaal even groot?). De ouders, die inmiddels weer welkom waren, konden de winnende playback-acts nog meekrijgen om vervolgens hun vermoeide kinderen mee terug naar huis te nemen.
Na zo’n geweldig weekend mag er een dikke dankjewel naar kampen keukenstaf, de leiders en andere vrijwilligers, de vele sponsors maar vooral voor de energieke, enthousiaste Olympiaantjes. Tot volgend jaar!
DISTRICTSCOMPETITIE MIDDEN-BRABANT DRIEBANDEN-KLEIN
Biljartsport
Volle winst ‘t Vaartje
Theo Laros had maar 47 beurten nodig. Zijn opponent hield echter gelijke tred, zodat een gelijkspel onvermijdelijk werd. Theo maakte nog wel een mooie serie van vier caramboles.
Kopman Mark Pijnenburg maakte zelfs een reeks van vijf. Hij pakte bekwaam de winst met het degelijke moyenne van 0.630.
Zeloo Financiële Dienstverlening
behoudt de leiding
In Heusden won team Zeloo Financiële Dienstverlening met 20-27 van team Concordia. De enige speler die verloor was Bart Hultermans. Bart kwam niet echt in zijn spel, waardoor verlies onvermijdelijk werd. Winst was er wel voor Embert Broekhoven en Ton Kemmeren. Beide spelers maakten een serie van vier. Embert finishte in 53 beurten en Ton had zelfs maar 48 beurtyen nodig. Door dit resultaat handhaaft team Zeloo zich aan de kop van de ranglijst. Doordat de concurrentie meer punten ver -
speelden is de voorsprong op de nummer twee gegroeid tot vijf punten.
Thuiswedstrijden Zeloo en ‘t Vaartje
Op donderdagavond 25 mei speelt team ’t Vaartje in eetcafé ’t Karrewiel in Dongen-Vaart een thuiswedstrijd. Het moet het dan opnemen tegen team Touché uit Hilvarenbeek.
Op deze dag speelt team Zeloo Financiële Dienstverlening tegen team DKM uit Oosterhout. Deze wedstrijd wordt gespeeld in café de Viersprong in Dongen. Beide wedstrijden beginnen om 19.30 uur.
SUDOKU © Persbelangen 7 6 2 7 3 5


Dongen JO10-2 2-3 JO8-1 - Madese Boys JO8-1JM Afgelast DVVC3 - Neerlandia’31-2 0-5 JO15-1 - Boxtel JO15-1 0-2 MO20-1 - Oosterhout MO20-1 3-0 UIT: Olympia’60 JO13-2 - JO13-1JM 1-4 Roosendaal JO14-2 - JO14-1JM 0-3 DHV1 - DVVC1 4-1 ONI4 - DVVC2(zat) 2-4 Zondag 21 mei UIT: FC Tilburg - DVVC2(zon) 3-6 Maandag 22 mei UIT: Waspik MO20-1 - DVVC MO20-1 1-4
- vv
WBDF-COMPETITIE

Darts
In Breda won team ’t Vaartje de laatste wedstrijd van de competitie met 4-5 van team Bullfighters. Dit team staat net iets hoger dan ’t Vaartje. Toch werd de winst nipt gepakt. In de singlewedstrijden was er winst voor Hans de Jong en Dennis Geerts. Davey Danyluk en Goof Verbunt moesten beiden een nederlaag incasseren. Beide spelers verloren in de laatste allesbeslissende leg. Ook in de koppelpartijen bleef
Doe mee met de wekelijkse De Koning Dongen prijspuzzel...
OPLOSSING WK 20: LEVENSLICHT
Horizontaal: 1 moorkop, 7 asperge, 13 april, 14 ais, 15 opeen, 16 amateur, 18 cynisme, 20 nat, 21 profeet, 23 per, 24 drek, 26 noren, 27 doel, 28 asurn, 30 Let, 31 tinne, 32 reep, 34 bras, 35 drug, 36 loog, 38 pits, 40 berg, 43 adres, 45 vei, 47 partij, 49 krot, 50 dorst, 52 mais, 53 wet, 54 worstje, 56 neg, 57 evenals, 59 machine, 61 regen, 62 ecu, 63 roede, 64 kledder, 65 snuiter.
Verticaal: 1 maandag, 2 opmars, 3 orateur, 4 rit, 5 klep, 6 parool, 7 asceet, 8 pont, 9 epi, 10 respons, 11 gemeen, 12 enerlei, 17 urn, 19 yen, 22 fret, 25 krediet, 27 diagram, 29 nerts, 31 troep, 33 pus, 34 bob, 37 vakwerk, 38 protegé, 39 kers, 41 graniet, 42 wijsgeer, 44 drevel, 45 vorser, 46 istmus, 48 tiende, 50 dol, 51 tja, 54 wand, 55 ecru, 58 ned, 60 hoi.
Prijspuzzelwinnaar wk 20: Frank de Geus Dongen
Volgende week maken wij de gelukkige winnaar of winnares bekend. De gewonnen prijs kan worden afgehaald bij: DE KONING DONGEN Hoge Ham 79, 5104 JC DONGEN
de stand gelijk. Twee gingen er naar ’t Vaartje en twee naar de tegenstander. De teamronde moest derhalve de beslissing brengen. Deze werd door de Dongense darters in de wacht gesleept.
Met dit resultaat eindigde team ’t Vaartje in de middenmoot op een verdienstelijke zevende plek. Het team heeft inmiddels besloten om ook volgend jaar door te gaan. Ook dan zullen de thuiswedstrijden gegooid worden bij café de Gouden Leeuw in Dongen.
...en win een OVERHEERLIJKE TAART!
Belgische Radio en Televisie (afk.) stellingname finesse belemmering overigens in het bijzonder (afk.) zoogdier 4 werppijltje zwaardwalvis meerriemige lasso
herexamen (afk.) distributeur 3 2 korte nota dunne overjas
etmaal zoogdier
8 gerstenat Algemene Bijstandswet (afk.) waskuip land in Europa
5 6 grondsoort
SPORT Lever uw oplossing vóór maandag 08.30 uur in via: puzzeldo@emdejong.nl of bij de redactie Hoge Ham 82 (Oplossing + Naam + Adres)
7 halm vrucht 1
Comité Européen de Normalisation

LAURENTIUSKERK
Zondag 28 mei 10.30 uur Pinksteren Eucharistieviering m.m.v. St Laurentiuskoor
Voorgangers: pastores Joost de Bont en Rob van Uden
Gebedsintenties:
Overleden ouders Leemans-Vermeulen en Zonen Ben, Leo, Antoon en kleindochter Annelies; Mien Zoontjes-Huijben; Els van Leijsen-Schellekens; Overleden ouders Jansen-Snoeren; Anny Vereggen de Wit; Voor het welslagen van een operatie
DOOP
Tijdens de viering wordt Viënna van Galen gedoopt. Door deze doop zal zij worden opgenomen in onze geloofsgemeenschap.
KERKBERICHT MIJZO
Dongepark
Vrijdag 26 mei
in het Theater
15.00 uur: Algemene bezinningsviering Thema: ‘De taal van het hart’ Voorganger: Irene Thomassen
Vrijdag 2 juni
in het Theater
15.00 uur: Katholieke viering (Eucharistie)
ZUSTERS FRANCISCANESSEN van Dongen
Kapelberichten
27 mei - 3 juni 2023
Zaterdag 27 mei
GEEN VIERING
Zondag 28 mei
10.30 uur Eucharistieviering
Hoogfeest van Pinksteren; - Voor de beide congregaties; - Zr
Theresio; - Maria Barendse – van Strien en overleden familie; Frits van Nunen en overleden familie; Bart en Cor van Strien – Lambregts en overleden familie; Wim van Dongen;
Maandag 29 mei
Tweede Pinksterdag om 10.30 uur
Eucharistieviering
Woensdag 31 mei
Jaargetijde Zr Marie Johannie
Mededeling Met Pinksteren is er een tweede collecte voor onze eigen Nederlandse missionarissen.
CHRISTELIJKE GEREFORMEERDE KERK ’s Gravenmoer
Zondag 28 mei
1e Pinksterdag:
10.00 uur: dhr. J. Molenaar
15.30 uur: ds. J.H. Bonhof
De kerkdiensten zijn ook te bekijken/beluisteren op www. cgk-sgravnmoer.nl
Colofon
Weekblad Dongen verschijnt wekelijks op donderdag in Dongen, Dongen-Vaart, Klein Dongen en ’s Gravenmoer in een oplage van 12.000 exemplaren.
EVANGELISCHE
KERK HOOP!
Dongen
zondag 28 mei
Aanstaande zondag, 28 mei, hebben wij geen reguliere samenkomst. De vierde zondag van de maand vinden er andere activiteiten plaats. We komen elke maand samen op de eerste en derde zondag van de maand. Voor meer informatie kunt u mailen naar info@ hoop-dongen.nl
HERVORMDE GEMEENTE
’s-Gravenmoer
Kerkdijk 15 www.hervormdsgravenmoer.nl
Zondag 28 mei 09.30 uur (1e Pinksterdag) ds. J. Boom; 18.30 uur ds. G.D. Hoff uit Rhenen.
Maandag 29 mei 09.30 uur (2e Pinksterdag) ds. J. Boom. U kunt deze diensten eveneens beluisteren via bovengenoemde website.
GEREFORMEERDE KERK
‘s-Gravenmoer
Vaartweg 28
www.gk-sgravenmoer.nl
Zondag 28 mei 09.30 uur (1e Pinksterdag) mevr.
M. de Bruin uit Molenaarsgraaf. U kunt deze dienst eveneens beluisteren via bovengenoemde website.
DE PAROCHIE DEZE WEEK
www.parochiedongen.nl - info@parochiedongen.nl
Parochiesecretariaat
Het parochiesecretariaat is gevestigd in het parochiecentrum, Hoge Ham 84, 5104 JK Dongen, tel. 0162-312561. Iedere morgen (maandag t/m vrijdag) van 9.00-11.30 uur kunt u hier terecht voor (in de schoolvakanties alleen op maandag en vrijdag):
. Wilt u thuis de Communie ontvangen dan kunt u, gedurende de openingstijden, contact opnemen met het Parochiecentrum tel. 0162-31 25 61.
. voor het opgeven van een doop, eerste communie en vormsel raadpleeg de website www.parochiedongen.nl
. het opgeven van gebedsintenties, de kosten zijn 12,- euro per intentie . het afhalen van een doopbewijs, . opgeven van huwelijk of jubileum, . het maken van afspraken met de pastores of een van de andere medewerkers in de parochie of alle andere vragen die u aan de parochie heeft.
Bereikbaarheid pastores
De pastores zijn bereikbaar via het secretariaat tel. 312561. Het kan zijn dat u MET SPOED een pastor wilt spreken. U kunt de dienstdoende pastor dan bereiken onder telefoonnummer 06-51175948. Wilt u van dit nummer alleen gebruik maken voor zaken die geen uitstel dulden. Arm in Arm – www.arminarmdongen.nl
De werkgroep zet zich in voor mensen in kwetsbare situaties. Van loketbegeleiding tot ondersteuning. Elk mens verdient een menswaardige manier van leven.
U kunt de werkgroep bereiken door te bellen en/of whatsappen naar 06-22884797 als u in Dongen woont, of naar 06-15142403 als u in ’s-Gravenmoer woont.
Ook kunt u het aanmeldformulier op de website van de werkgroep gebruiken. Op de website www.arminarmdongen.nl vindt u alle info over de werkgroep. Mailen kan ook: info@arminarmdongen.nl Wacht niet tot het te laat is.
PROTESTANTSE GEMEENTE
Dongen-Rijen
Zondag 28 mei: Viering van het Pinksterfeest vanuit de Oude Kerk, Kerkstraat 56 in Dongen. Aanvang 10.00 uur. Voorganger ís ds. Henrieke ten Thije. Muzikale medewerking wordt verleend door Gospelkoor TICGC uit Tilburg. Tijdens deze dienst zal één van onze leden belijdenis afleggen van zijn geloof. Bij goed weer is er na afloop in de
MEMORANDUM - WEEKENDDIENSTEN
HUISARTSEN Huisartsenpost Amphiaziekenhuis in Oosterhout (rechts achter op parkeerplaats van het Amphia, een laag wit gebouw) is op weekdagen geopend van 17.00 uur tot 08.00 uur en in de weekenden en op feestdagen van 08.00 tot 08.00 uur. Tel.: 0162 - 435000.
APOTHEKEN Paukenlaan 1 en Kloosterpad 13 in Dongen Ma. t/m vr. 08.00-17.30 uur of Dienstapotheek regio Oosterhout, locatie Pasteurlaan Tel. 0162-490544
DIERENARTSEN DIER EN DONGEN Hoge Ham 106, Dongen Tel: 0162 - 32 55 55 Spreekuur op afspraak: alle werkdagen 09.00-12.00 en 13.30-17.00 uur ma., wo., vrij. 18.00-19.00 uur
di., do. 17.00 - 18.00 uur
BLOEDAFNAME PRIKPOST DIAGNOVUM
Sport- en gezondheidcentrum De Vennen, Deken Batenburgstraat
2, Dongen Ma t/m vrij: 8.30 – 9.30 uur
Voor actuele informatie zie www.diagnovum.nl/locaties of bel 013-5393636
Grootouders-kleinkindtoernooi
BLOEDAFNAME SHL-Groep/trombosedienst SRTB Voor bloedafname of inleveren van humaan materiaal (vrije inloop tijdens openingstijden) t.b.v. laboratoriumonderzoek op verzoek van uw zorgverlener en trombosedienst ( www.srtb.nl ). Actuele informatie: www.shl-groep.nl GGZ Breburg Groep Heuvelstraat 33, Dongen di + do: 08.30-09.30 uur Medisch Centrum De Beljaart Kloosterpad 13a, Dongen ma t/m vrij: 08.00-11.00 uur
ruïne gelegenheid voor gesprek en ontmoeting bij koffie en thee. Bij minder goed weer zal dit zoals gebruikelijk in de Ontmoeting plaatsvinden. Voor meer informatie over deze viering wordt verwezen naar het afzonderlijke artikel in dit blad. Belangstellenden die de dienst thuis willen volgen, verwijzen wij naar de uitzending via de website van de kerk www. pkndongen-rijen.nl, of via youtube.com en dan in de zoekkolom invullen ’protestantse gemeente Dongen en Rijen’. Dit kan zowel rechtstreeks als op een later tijdstip.
Woensdag 31 mei:
Van 10.00 tot 12.00 uur in de Ontmoeting, Kerkstraat 52n: inloophuis. Iedereen is van harte welkom om gezellig aan te schuiven voor gesprek en ontmoeting bij koffie en thee.
Deze week hield Jeu de Boules Club Dongen haar jaarlijks terugkerend opa-oma-kleinkind toernooi.

Elk jaar organiseert Jeu de Boules Club Dongen een gezelligheidstoernooi voor grootouders en kleinkinderen. Dit jaar hadden er maar liefst 34 equipes ingeschreven voor dit toernooi, dus een clublid met haar/zijn kleinzoon/ kleindochter. De leeftijden liepen nogal uiteen: de jongste was 8 jaar en de oudste maar liefst rond de 30 jaar! De dames van de WECO, Corry en Jacqueline, hadden op basis van leeftijden een tweetal poules gemaakt, waarbij 3 wedstrijden gespeeld moesten worden. Vanaf 10 uur kon iedereen zich melden bij de wedstrijdtafel en rond half 11 begonnen de eerste wedstrijden van dit toernooi. Er was één bijzondere afspraak gemaakt: de clubleden mochten NIET schieten en de kleinkinderen onder de 18 jaar wel! Dit zou het spel zeker ten goede komen, had de ervaring geleerd. De mensen achter de bar en de keuken konden zich intussen voorbereiden op de lunch, want het was wel duidelijk dat er behoorlijk gegeten zou worden. Anneke en Christ hadden bardienst en Jeanne, Wim en Kees zorgden voor de inwendige mens. Er werd al vroeg in de ochtend gebakken om aan alle vraag te kunnen voldoen.
Je merkte al gauw dat enkele kleinkinderen voor de hoofdprijs gingen strijden en dat anderen meer oog en oor hadden voor elkaar. Op zich niet verkeerd hoor, want het was per slot van rekening een gezelligheidstoernooi! Maar, onder ons gezegd en gezwegen… er zat zeker talent bij, zij het ietwat verborgen. Misschien kunnen we deze talenten

Maandagmiddagbridge in de Cammeleur
Uitslag maandagmiddag 22 mei
Uitgever Uitgeverij Em. de Jong bv
Postbus 8 5110 AA Baarle-Nassau Visweg 8 5111 HJ Baarle-Nassau Tel: 013-5075534 www.uitgeverijemdejong.nl uitgeverij@emdejong.nl
Aanleveren kopij Ga naar www.uitgeverijemdejong.nl en kies voor aanleveren, redactioneel.
WILT U OOK IN DIT MEMORANDUM VERMELD WORDEN?
MAIL: UITGEVERIJ@ EMDEJONG.NL OF BEL: JAN ROKS 06-21298146
Redactie dongen@emdejong.nl
Correspondenten Ruth Wilmans 06 - 28428246 ruthweekblad@outlook.com Lia van Gool 06 - 53245070 liavangool2909@gmail.com
Advertenties (zakelijk) Jan Roks, 06-21298146
E-mail adres voor advertenties uitgeverij@emdejong.nl
1. Hh. J. Voesenek - L. de Jong 64,17%
2. Mevr. M. Lenaerts - Hr. G. Vermeulen 63,00%
3. Dms. L. Schellekens - N. Emmen 59,63%
Op maandagmiddag heeft iedereen een kans op een prijs. Deze keer was er een prijs voor het paar dat eindigde op de 1e plaats, waardoor de heren Voesenek - De Jong, naast het applaus voor het behalen van de eerste plaats, ieder 1/5 staatslot won.
Particuliere advertenties en Zoekertjes Via www.uitgeverijemdejong.nl, kies voor aanleveren. Bezorgklachten ga naar www.uitgeverijemdejong.nl en kies voor bezorging om een bezorgklacht door te geven of bel naar Uitgeverij Em. de Jong
later alsnog inschrijven als lid van onze vereniging?
Na 3 wedstrijden kon de WECO de einduitslag opmaken en uiteraard ook bekendmaken. Allereerst werden de betreffende vrijwilligers bedankt voor hun inzet voorafgaande en tijdens dit toernooi en daarna ontvingen alle gasten een medaille voor hun deelname. Hierna werd even een korte pauze ingelast om “een aantal barkaarten te trekken”: er wordt een paar keer per jaar een trekking gedaan onder de volle ingeleverde barkaarten. Deze keer werden er maar liefst 6 barkaarten verloot.
Tot slot werd de uitslag bekend gemaakt van dit toernooi. De winnende equipes uit beide poules werden in het zonnetje gezet en kregen uit handen van Corry en Jacqueline een toepasselijk prijsje. Dat waren Willemieke van Gils met Mees Tempelaars en in de andere poule waren dat Piet Maas en Imke Versteeg.
Wij feliciteren de winnaars van dit gezelligheidstoernooi van HARTE met het behalen van die eerste plaatsen. Het was een geslaagde dag en we hopen dat we volgend jaar weer iedereen mogen verwelkomen op dit traditionele boulestoernooi.
WECO Jeu de Boules Club Dongen

Een extra exemplaar van het weekblad kunt u op één van de onderstaande adressen ophalen:
Dongen: In ‘t Groen Groenten en Fruit, Klein Dongenseweg 78, AVIA Tichelrijt service bv, Steenstraat 18 Nettorama, Kanaalstraat 36 Jumbo, Mgr. Schaepmanlaan 8
Albert Heijn, Looiershof 1 Boerenbond, Tramstraat 34
Spar supermarkt, Europaplein
Cigo,Looiersplein 30
‘s Gravenmoer: COOP supermarkt, Molendijk 1B
Zag u de verschillen niet goed? Kom langs bij:
Hoge Ham
Druk
Janssen/Pers Rotatiedruk 100% dochteronderneming van /weekbladdongen








